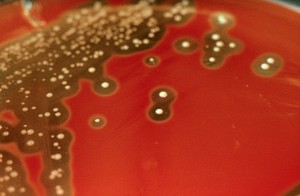
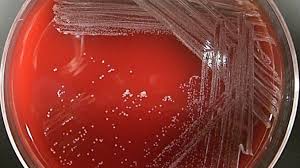
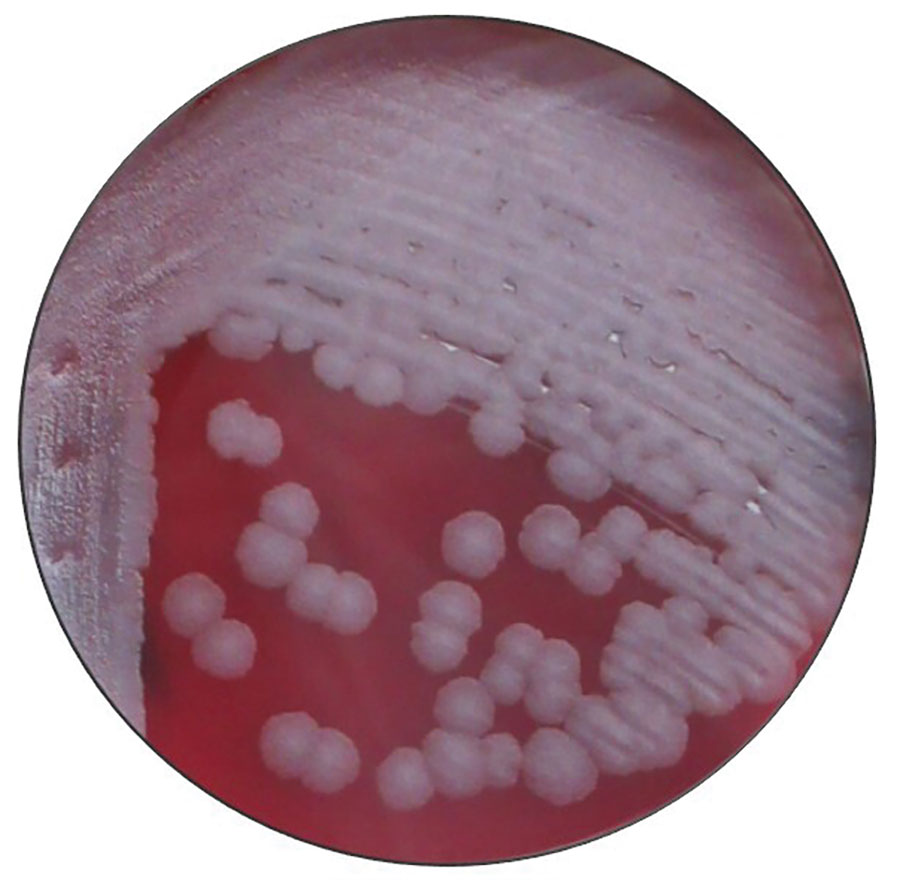

Bacteriology
[bak-teer-ee-ol-uh-jee]
Course Detail
Bacteriology
List of Contents
- General Introduction
- Staphylococcus
- Streptococcus
- Pneumococcus
- Neisseria
- Corynebacteria
- Bacillus
- Clostridium
- Coliforms
- Salmonella
- Shigella
- Yersinia
- Vibrio, Aeromonas and Plesiomonas
- Campylobacter and Helicobacter
- Pseudomonas and Moraxella
- Haemophilus, Pasteurella and Actinobacillus
- Bordetella and Francisella
- Brucella
- Mycobacterium Tuberculosis
- Other Mycobacteria
- M. leprae and M. lepraemurium
- Treponema, Borrelia and Leptospira
- Mycoplasma
- Actinomycetes
- Rickettsia and Cocxiella
- Chlamydia
- Other Important Bacteria
Introduction
Bacteria (singular bacterium) are ubiquitous, mostly free-living organisms often single celled and reproduce by binary fission. Typically a few micrometres in length, bacteria were among the first life forms to appear on Earth, and are present in most of its habitats. Bacteria inhabit soil, water, acidic hot springs, radioactive waste, and the deep biosphere of Earth's crust. Superficially, bacteria appear to be relatively simple forms of life; in fact, they are sophisticated and highly adaptable.
Humans and most animals carry millions of bacteria mostly in the gut and on the skin. Most of the bacteria in and on the body are harmless or rendered so by the protective effects of the immune system, though many are beneficial, particularly the ones in the gut. However, several species of bacteria are pathogenic and cause several infectious diseases.
In developed countries, 90 percent of documented infections in hospitalized patients are caused by bacteria. These cases probably reflect only a small percentage of the actual number of bacterial infections occurring in the general population, and usually represent the most severe cases. In developing countries, a variety of bacterial infections often exert a devastating effect on the health of the inhabitants. Malnutrition, parasitic infections, and poor sanitation are a few of the factors contributing to the increased susceptibility of these individuals to bacterial pathogens.
(Reference Baron S, editor. Galveston (TX): University of Texas Medical Branch at Galveston; 1996.)
Bacteriology is the branch of biology that studies the morphology, ecology, genetics, biochemistry, identification, classification, and characterization of bacteria.

Antony van Leeuwenhoek is largely regarded as the father of Bacteriology having discovered protsista and bacteria, which at the time he named them animalcules.
My work, which I've done for a long time, was not pursued in order to gain the praise I now enjoy, but chiefly from a craving after
knowledge, which I notice resides in me more than in most other men. And therewithal, whenever I found out anything remarkable, I
have thought it my duty to put down my discovery on paper, so that all ingenious people might be informed thereof.
Antonie van Leeuwenhoek,
in a letter dated 12 June 1716.
He (Antony) was the first even to think of looking and certainly, the first with the power to see. Using his own deceptively simple, single-lensed microscopes, he did not merely observe, but conducted ingenious experiments, exploring and manipulating his microscopic universe with a curiosity that belied his lack of a map or bearings. Leeuwenhoek was a pioneer, a scientist of the highest calibre. Nick Lane, 2015.
Staphylococcus
The Family Micrococcaceae consists of Gram-positive cocci, which may be aerobic or anaerobic, and are arranged in tetrads or clusters. Micrococcaceae consists of four genera, Staphylococcus, Micrococcus, Planococcus, and Stomatococcus.
The genus Staphylococcus consists of 32 species, most of which are animal pathogens or commensals. The bacteria belonging to this genus are aerobic and facultative anaerobic, catalase positive, oxidase negative, and are arranged in clusters, pairs, or tetrads.
Staphylococcus aureus
Staphylococcus aureus is the most important human pathogencausing diseases ranging from superficial skin lesions like folliculitis to deep-seated abscess and various pyogenic infections like endocarditis, osteomyelitis, etc. The bacterium also causes toxin-mediated diseases, such as food poisoning, toxic shock syndrome (TSS), and staphylococcal scalded skin syndrome (SSSS).
Staphylococci have the following characteristics:
- They are Gram-positive cocci, measuring around 1 µm in diameter.
- They are nonmotile, nonsporing.
- Although the are noncapsulated, they contain a microcapsule, which can only be visualized by electron microscope, but not by a light microscope.

Culture
Staphylococcus species can grow on several types of cultures including Mueller Hinton agar, nutrient agar, blood agar or MacConkey agar.
On nutrient agar, Staphylococcus aureus produces round convex well defined colonies about 2-4mm in diameter. The colonies have asmooth
shiny surface.
On blood agar, Staphylococcus aureus produces clear zones of hemolysis surrounding the colonies.
On MacConkey agar, Staphylococcus aureus produces small pink colonies due to lactose fermentation.
Staphylococcus aureus is selectively grown on Mannitol salt agar or milk agar or glycerol monoacetate agar. Most strains of Staphylococcus aureus ferment mannitol resulting in acid production which gives rise to yellow zones around the colonies.
Staphylococcus aureus produces turbidity in liquid media with no pigment observed
Biochemical tests
Staphylococcus aureus is:
- Coagulase positive
- Phosphatase positive
- Catalase positive
- Oxidase negative
- It liquifies gelatin, hydrolyzes urea, is methyl red positive but indole negative.
Most staphylococcus strains can withstand moist heat at 60oC for 30 minutes but die beyond 30 minutes. They are also killed rapidly by disinfectatnts and aniline dyes such as Crystal violet.
Pathophysiology
S. aureus are pyogenic (pus producing) bacteria that cause localized lesions in contrast to streptococci that are spreading in nature. Staphylococci adhere to the damaged skin, mucosa, or tissue surfaces. Diseases and conditions caused by Staphylococcus aureus include:
- Staphylococcal skin infections include impetigo, folliculitis, furuncles, carbuncles, paronychia, surgical wound infection, blepharitis, and postpartum breast infection.
- S. aureus is the most common cause of boils. The infection is acquired either by self-inoculation from a carrier site, such as the nose or through contact with another person harboring the bacteria.
- Bacteremia and septicemia may occur from any localized lesion, especially wound infection or as a result of intravenous drug abuse.
- S. aureus is an important cause of acute bacterial endocarditis, of normal or prosthetic heart valves, which is associated with high mortality.
- S. aureus is the most common cause of osteomyelitis in children. The bacteria reach bone through blood stream or by direct implantation following trauma.
- S. aureus causes pneumonia in postoperative patients following viral respiratory infection, leading to empyema; it also leads to chronic sinusitis.
- S. aureus causes deep-seated abscesses in any organ after bacteremia.



Toxins
The toxins produced by Staphylococcus aureus include toxic shock syndrome toxin, enterotoxin, exfoliative toxin, leukocidins, and hemolysins. These toxins can cause staphylococcal food poisoning, staphylococcal toxic shock syndrome, and staphylococcal scalded skin syndrome.
Hospital-acquired S. aureus infections
This is the most common cause of hospital-acquired infections. Certain strains of S. aureus causing hospital infections are known as hospital strains. These strains are usually resistant to penicillin, methicillin, and other routinely used antibiotics.
Diagnosis and Treatment
The presense of Staphylococcus aureus can be achieved through several techniques.
- Microscopy - observe the gram positive cocci. However, this is not conclusive.
- Culture: the use of selective media combined with biochemical tests such as coagulase, phosphatase, catalase and oxidase test.
When antimicrobial therapy is needed, the duration and mode of therapy are largely dependent on the infection type as well as other factors. In general, penicillin remains the drug of choice if isolates are sensitive (MSSA, or methicillin sensitive S. aureus strains) and vancomycin for MRSA strains.
Other Staph species
Staphylococcus epidermidis
Infection occurs in immunocompromised hosts, such as those suffering from Neutropenia, particularly in association with intravenous catheters and other prosthetic devices, such as heart valves. It can also cause sepsis in neonates, osteomyelitis, wound infections, vascular graft infections, and mediastinitis.
Staphylococcus saprophyticus
Is associated with urinary tract infection by endogenous spread in colonized women. It adheres to the epithelial cells lining the urogenital tract causing dysuria, pyuria, and hematuria. In males, it causes urethritis, catheter-associated urinary tract infections, prostatitis in the older ages, and rarely, sepsis and endocarditis.
Streptococcus and Enterococcus
Streptococci are aerobic and facultatively anaerobic Grampositive cocci, arranged in pairs, or chains. The enterococci are facultative anaerobes. They require complex nutrients for their growth.
Streptococcus species are part of the normal flora in humans and animals. They are nonmotile, nonsporing spherical or ovoid cocci with a hyaluronic acids capsule. They are catalase negative (which differentiates them from Staphylococcus) and are relatively difficult to culture, they require enriched media such as blood agar for them to grown.
Some of the major species of importance include:
- Streptococcus pyogenes
- Streptococcus agalactiae
- Streptococcus equisimilis
- Streptococcus bovis
- Streptococcus sanguis
- Streptococcus mutans
Streptococcus pyogenes
S. pyogenes is the most important human pathogen causing:
1. Pyogenic infections, such as bacterial pharyngitis and
cellulitis.
2. Toxin-mediated diseases, such as scarlet fever and toxic
shock syndrome.
3. Immunologic diseases, such as acute glomerulonephritis
(AGN) and rheumatic fever.
Characterization of S. pyogenes
Gram positive cocci about 0.6-1µm in diameter and arranged in long chains. Some strains produce a capsule during the first 2-4 hours of growth. The capsule contains hyaluronic acid which is chemically similar to the host's connective tissue so it renders the bacteria non-antigenic.
S. pyogenes can grow on blood agar producing small white colonies with a clear zone of hemolysis.
Addition of crystal violet to blood agar makes the media highly selective for this bacteria because it inhibits the other gram positive bacteria.
Biochemical reactions
S. pyogenes shows following biochemical reactions:
- Catalase negative, which distinguishes them from staphylococci.
- They ferment many sugars, producing acid but no gas. They do not ferment ribose
- They are not soluble in bile.
- They cause hydrolysis of pyrrolidonyl naphthylamide (PYR).
Physcial and Chemical Agents
Streptococci are killed by heating at 54oC for 30 minutes and by most common disinfectants.
Capsule: The cell wall of the Streptococcus is surrounded by a capsule. The capsule is nonantigenic and weakly antiphagocytic. It acts like a barrier between the complement proteins bound to the bacteria and the phagocytic cells, thereby preventing phagocytosis of the bacteria.
Toxins
S. pyogenes produces toxins such as Streptococcal pyrogenic exotoxins, Hemolysins, Streptolysin O, Streptolysin S and Pyrogenic exotoxins which are associated with the pathogencity of various diseases including Scarlet fever and Streptococcal toxic shock syndrome.
Diagnosis
- Microscopy
- Culture: Throat swab culture is the most specific method for diagnosis of streptococcal pharyngitis. Ideally, the throat swab specimen should be collected from tonsils and posterior part of the oropharynx because more number of bacteria are present at this site than in the anterior part of mouth. After collection of the specimen, they are plated immediately on the blood agar plate, and in case of delay they are sent to the laboratory in Pikes transport medium.
Streptococcus agalactiae
S. agalactiae are found as normal flora in the genitourinary tract and lower gastrointestinal tract.
S. agalactiae in pregnant women can cause urinary tract infection particularly immediately after delivery. In nonpregnant women and in men, S. agalactiae can cause infections, such as osteomyelitis, arthritis, peritonitis, and skin infections.
Streptococcus equisimilis
S. equisimilis resembles S. pyogenes in fermenting trehalose but differs from it by not fermenting ribose. It causes upper respiratory tract infections and also pneumonia, osteomyelitis, endocarditis, brain abscess, and puerperal sepsis. S. equisimilis shows tolerance to treatment with penicillin; therefore patients may not respond to treatment with penicillin.
Streptococcus bovis and Streptococcus equinus are the nonenterococcal streptococci, which are associated with human infections, such as urinary tract infections and rarely endocarditis. They are susceptible to penicillins.
S. sanguis is the most common causative agent of bacterial endocarditis in individuals with preexisting heart lesions.
S. mutans is an important causative agent of dental caries. It splits dietary sucrose, producing acid and a dextran. The acid damages the dentine. The dextran binds together exfoliative epithelial cells, mucus, food debris, and bacteria to form dental plaques.
Enterococcus
The enterococci are Gram-positive, spherical, oval, or coccobacillary and are arranged in pairs and short chains. Most of the species are nonmotile and noncapsulated. They grow at a temperature range of 35-37oC. Colonies on blood agar media are 1-2 mm in diameter and alpha-hemolytic (actually nonhemolytic; appearance of alpha-hemolysis is due to the production of the enzyme peroxidase rather than hemolysins). Some cultures are beta-hemolytic on agar containing rabbit, horse, or human blood but not on agar containing sheep blood.
Enterococci possess two important virulence factors: (a) aggregation substances and (b) carbohydrate adhesions. Aggregation substances are hair-like proteins that facilitate binding of bacteria to the epithelial cells. Carbohydrate adhesins facilitate binding of cocci to host cells gelatinase.
The enterococci are commonly found in gastrointestinal and genital tract of humans and animals. Enterococci are nonpathogenic.
Pneumococcus
Pneumococcus was previously classified as Diplococcus pneumoniae. The bacterium has now been reclassified as Streptococcus pneumoniae due to its genetic similarities to Streptococcus.
Streptococcus pneumoniae
They are Gram-positive cocci measuring 0.5-1.25µm in diameter. Older cells may decolorize rapidly and might appear Gram negative. In clinical specimens, they appear typically 'lanceolate shaped' with one end pointed and the other end round. They are arranged in pairs (diplococci) with the broad ends in apposition to each other. In cultures, they usually appear more rounded and are arranged in short chains
They are encapsulated, non-sporing and non-motile.
Culture
S. pneumoniae is an aerobe and a facultative anaerobe. It grows at an optimum temperature of 37oC (range 25-42oC) and pH 7.8 (range 6.5-8.3). The growth is enhanced by the presence of 5-10% Carbon dioxide. Pneumococci are fastidious. They grow only on an enriched media, such as blood agar or chocolate agar supplemented with blood products, which will supply nutrients, pH buffers, etc.
Colonies on blood agar in anaerobic incubation show beta-hemolysis (greenish discoloration), but show alpha-hemolysis in aerobic incubation conditions.
After overnight incubation, capsulated strains produce round and mucoid colonies measuring 1-3 mm in diameter. The type 3 S. pneumoniae (which is most virulent), produce copious quantities of capsular material and hence produce large mucoid colonies. Noncapsulated strains produce small and flat colonies.
On prolonged incubation, the colonies undergo autolysis and the centers become flattened or depressed while the edges become raised, giving the colonies a typical draughtsman appearance.
The capsules are present in strains isolated from clinical specimens but are lost after repeated cultivation. This is called smooth to rough variation. Noncapsulated rough (R) strains are not virulent; these forms arise as spontaneous mutants and outgrow the parental smooth (S) strains in artificial culture.

Biochemical reactions
S. pneumoniae ferments many sugars, producing acid only
but no gas.
S. pneumoniae ferments inulin, and this is an important test
to differentiate it from those streptococci that do not ferment
inulin.
S. pneumoniae produces an autolytic enzyme amidase, which
solubilizes the peptidoglycan of the cell wall; hence in old
cultures, typical draughtsman colonies are formed. This
autolytic activity can be augmented by surface active agents,
such as bile and bile salts.
Pneumococci are catalase and oxidase negative.
Pneumococci are delicate bacteria. They are killed by heating at 52oC for 15 minutes and by usual strengths of disinfectants.
Antigenic Structures
Capsule: The polysaccharide capsule surrounds the cell
wall. The capsule is essential for virulence, its role being to
protect the cocci from phagocytosis.
Cell wall: It consists of peptidoglycan, teichoic acid, and
proteins.
Peptidoglycan: Peptidoglycan confers rigidity to the cell
wall.
Serotyping of pneumococci
Agglutination of the bacteria with type-specific antiserum by co-agglutination (Co-A) test.
Capsular swelling reaction with type-specific antiserum by 'Quellung reaction'.
Virulence Factors
Pneumococci cause disease by their capacity to multiply
in host tissues by avoiding the host defense mechanisms
Virulence factors
The Capsule: Virulent strains of S. pneumoniae have a complex
polysaccharide capsule.
Pneumolysin: Pneumolysin is a toxin produced by
pneumococci. The toxin alters the mucociliary clearance
function of respiratory epithelium and inhibits phagocytic cell
oxidative burst essential for intracellular killing of the bacteria.
IgA protease: The enzyme produced by pneumococci disrupts
secretory IgA-mediated clearance of the bacteria and thereby
enhances the ability of the bacteria to colonize mucosa of the
upper respiratory tract.
Host immunity
Host immunity is type specific with production of anticapsular antibodies. Natural immunity follows infections as well as colonization.
Pathogenicity
Ninety serotypes of S. pneumoniae have been identified with varying degrees of pathogenicity, out of which 23 serotypes are known to cause disease in humans.
- Pneumonia: S. pneumoniae is the leading cause of bacterial pneumonia, both lobar and bronchopneumonia. S. pneumoniae is the most common bacterial cause of childhood pneumonia, especially in children younger than 5 years.
- Meningitis: Pneumococcus is the most common cause of pyogenic meningitis in children, although the condition can occur in all age groups. Meningitis is always secondary to other pneumococcal infections, such as pneumonia, bacteremia, infections of the ear or sinuses.
- Sinusitis: Sinusitis and otitis media occur in patients with prior viral infections. The viral infection lowers the mucosal immunity, facilitating the invasion by S. pneumoniae.
Habitat
S. pneumoniae is a normal inhabitant of throat and nasopharynx. Nasopharyngeal colonization occurs in approximately 5-75% of the population. Colonization is more common in children than in adults. The colonization occurs at about 6 months of age.
Treatment
Most pneumococci are susceptible to penicillin, amoxicillin, and erythromycin.
Prevention and Control
Vaccines play an important role in prevention of pneumococcal diseases.
Neisseria
This genus consists of Gram-negative, aerobic cocci that are nonsporing, nonmotile and typically arranged in pairs
(i.e., diplococci) with adjacent sides flattened together. Neisseria are oxidase positive and mostly catalase
positive. They ferment sugars resulting in production of acid but no gas.
The genus Neisseria consists of 10 species. Neisseria gonorrhoeae
and Neisseria meningitidis are the two important species that cause
human infections. The other species are commensals and only cause opportunistic infections.

Neisseria gonorrhoeae
N. gonorrhoeae is a strict human pathogen causing gonorrhea, one of the most common sexually transmitted disease worldwide. It can also be transmitted by the mother's genital tract to the newborn during birth causing ophthalmia neonatorum.
They pathogens are mostly intracellular, found inside the polymorphonuclear leukocytes with some cells containing as many as a hundred cocci. Pus smears show the intracellular kidney-shaped cocci, typically arranged in pairs with concave sides facing each other. Freshly isolated bacteria may be capsulated.
Culture N. gonorrhoeae is fastidious, requiring complex media such as blood or chocolate agar for growth. They are aerobes but can also grow anaerobically. They grow optimally at a temperature range of 35-36oC. They fail to grow at temperature less than 25oC or greater than 37oC. The growth of bacteria is enhanced by incubation in humid atmosphere supplemented with 5-10% Carbon dioxide.
Biochemical tests Gonococci ferment glucose with the production of acid but no gas. They do not ferment maltose, lactose, sucrose, or fructose. This is an important feature to differentiate N. gonorrhoeae from N. meningitidis. N. gonorrhoeae utilizes glucose only, whereas N. meningitidis utilizes both glucose and maltose. They do not reduce nitrates, and they do not produce hydrogen sulfide. They are oxidase and catalase positive.
Gonococci are highly delicate bacteria. They die rapidly on drying. They are also killed by soap, and many other disinfectants, such as phenol, chlorhexidine, and hexachlorophene and antiseptics. They are killed by temperatures lower than 25oC. They can be stored for long periods by freeze drying or storing in liquid nitrogen.
Pathogenesis and Immunity
N. gonorrhoeae causes disease both by multiplying in tissues and by causing inflammation. The bacteria do not produce any toxins. The cocci contain several antigens such as the capsule, Pili, Por proteins, Lipo-oligosaccharides, Beta-lactamase, IgA protease and Plasmids.
The main host defense mechanisms against gonococci are antibodies (IgA and IgG), complement, and neutrophils. Antibody response to gonococci is characterized by the production of serum IgG antibodies. IgG3 is the predominant immunoglobulin.
Gonorrhea
Gonorrhea is a sexually transmitted disease restricted to the urethra in men and cervix in women. The incubation period varies from 2 to 8 days.
Gonorrhea in men:
A symptomatic acute infection is seen in
approximately 95% of all infected men. Urethritis is the major
clinical manifestation, with burning micturition and serous
urethral discharge as the initial manifestation. Subsequently,
the discharge becomes more profuse, purulent, and even bloodtinged.
Acute epididymitis, prostatitis, and periurethral abscess
are rare, but are noted gonococcal complications in men.
Gonorrhea in women:
In women, the endocervix is the primary
site (80-90%) of infection because gonococci invade only the
endocervical columnar epithelial cells. The bacteria cannot
infect the squamous epithelial cells in the vagina of postpubescent
women. Urethra (80%), rectum (40%), and pharynx
(10-20%) are other sites of infection in women. The infection
is mostly asymptomatic in women. The presence of vaginal
discharge, dysuria, dyspareunia, and mild lower abdominal
pain are the common symptoms in symptomatic women
Pelvic inflammatory disease (PID) is the most important complication in females following gonococcal infection. Increased vaginal discharge or purulent urethral discharge, dysuria, lower abdominal pain, and intermenstrual bleeding are the common symptoms
Ophthalmia neonatorum is a nonsexually transmitted infection caused by N. gonorrhoeae. This is a condition of bilateral conjunctivitis of a neonate born through vaginal delivery if the mother is infected. However, transmission to the newborn can also occur in utero or in the postpartum period. The idease is associated with pain in the eyes, redness, and purulent discharge. It can result into blindness rapidly, so a proper diagnosis is essential.
Treatment
Sulfonamides were used from as early as 1935 for treatment of gonorrhea. In the beginning, all the strains of gonococci were sensitive to sulfonamides but subsequently, they developed resistance to these antibiotics. Penicillin is the drug of choice for penicillin-sensitive strains of N. gonorrhoeae. Tetracyclines are no longer given for gonococcal infection because of the prevalence of tetracycline resistance. Resistance to ciprofloxacin has also been increasingly documented in Southeast Asia, Africa, and Australia.
Prevention is achieved through health education, early detection of cases, tracing of contacts, and follow-up of screening of sexual contacts is important in the prevention of gonorrheal epidemics. Furthermore, the prevention of gonorrhea involves the promotion of safe sex and individual counseling.
Neisseria meningitidis
N. meningitidis causes a spectrum of diseases ranging from meningococcemia (rapidly fatal) to a transient bacteremia. It is the second most common cause of community-acquired meningitis in adults.
N. meningitidis are Gram-negative, spherical, or oval cocci arranged in pairs with the adjacent sides flattened. The cocci are generally intracellular in Polymorphonuclear leucocytes, in smears from pus cells and other specimens. They measure 0.6-0.8 µm in diameter. They are nonmotile and nonsporing and freshly isolated bacteria are usually capsulated.
Meningococci are fastidious bacteria with complex nutritional requirements. They do not grow on ordinary media, but grow well on the medium enriched with blood or serum, such as blood agar, chocolate agar,
Biochemical Reactions
N. meningitidis is oxidase and catalase positive. These two tests are important biochemical markers for preliminary identification of this organism. In summary, they are Gram-negative diplococci arranged in pairs. On blood agar, they produce convex, gray, and translucent colonies. They are Oxidase positive and Catalase positive. They ferment glucose and maltose with production of acid, but do not ferment sucrose or lactose.
Pathogenesis of meningitis
Initially, N. meningitidis causes a localized infection by colonizing the nasopharynx.
Invasion of blood stream is the most common mode of spread
Immunity
Meningococci in the nasopharynx induce a humoral antibody response, and most people acquire immunity to meningococcal disease by age of 20 years. Maternal antibodies provide protection to infants for the first 3-6 months of life.
Meningitis
Meningococcal meningitis caused by N. meningitidis is most common in children and young adults. It is a febrile illness of short duration characterized by headache and stiff
Some clinical signs include headache and stiff neck. Lethargy or drowsiness is frequent. Confusion, agitated delirium, and stupor are rarer. Mental obtundation and at times coma can result.
Prognosis of meningitis is good, and the patients recover completely on immediate treatment with appropriate antimicrobial therapy.
Treatment
Prompt and specific antimicrobial therapy of meningococcemia or meningococcal meningitis is most crucial. Intravenous penicillin G is the recommended drug for the treatment of meningococcal disease.
Corynebacteria
The genus Corynebacterium consists of a diverse group of bacteria including animal and plant pathogens. They are shaped like rods and are Gram-positive, aerobic or facultative anaerobic, nonmotile, non-sporing and catalase-positive. Gram staining shows bacteria in short chains or clumps resembling characteristic Chinese letters.
The genus Corynebacterium consists of 46 species, of which at least 30 species are known to be associated with human diseases. Corynebacterium diphtheriae, the causal agent of the disease diphtheria is the most widely studied species.
Corynebacterium diphtheriae
Diphtheria is an acute upper respiratory tract illness characterized by sore throat, low-grade fever, and an adherent membrane on the tonsil(s), pharynx, and/or nose.

Properties
C. diphtheriae is a Gram-positive bacillus showing maximum pleomorphism on Gram staining. The bacteria appear in palisades or as individual cells lying as sharp angles to each other in V and L formation. This Chinese letter pattern formation or cuneiform arrangement is caused by the incomplete separation of the daughter cells during division when the organism is grown on nutritionally inadequate media. Most of the bacteria have 2-3 granules at the swollen ends known as metachromatic granules, Babe- Ernest's granules, or volutin granules, which give reddish purple color when stained with Loeffler alkaline methylene blue.
Culture
C. diphtheriae is an aerobic and facultative anaerobic organism
but grows best under aerobic conditions. It grows at 37oC and
at a pH of 7.2-7.4 on media enriched with blood, serum, or egg.
C. diphtheriae is classified into three distinct biotypes (mitis, intermedius, and gravis) based on the colony morphologies on cysteine-tellurite agar;
- Mitis colonies are small, round, convex, and black.
- Intermedius colonies are small, flat, and gray.
- Gravis colonies are large, irregular, and gray.
Biochemical reactions
C. diphtheriae ferments many sugars (glucose, galactose, maltose,
and dextrin) producing acid but no gas. it does not ferment lactose, mannitol, and sucrose. Diphtheria
bacilli are readily killed by heating at 58oC for 10 minutes
and at 100oC for 1 minute. They are destroyed by the usual
strengths of antiseptics.
Pathogenesis and Immunity
Diphtheria is a toxin-mediated bacterial disease. Diphtheria toxin is produced only by strains of C. diphtheriae that are lysogenized with bacteriophages that contain the structural gene (tox gene) for the toxin molecule. When DNA of the phage becomes integrated into the genetic material of C. diphtheriae, the bacteria develop the ability to produce the polypeptide toxin
C. diphtheriae enters the body through the upper respiratory tract but can also enter through the skin, genital tract, or eye. Infection begins by adherence of the bacteria at the infected site. The growth of the bacteria can only occur oral cavity, but toxemia and systemic manifestation of diphtheria occurs due to absorption of toxin from the site of membrane.
In diphtheria, immunity against clinical diseases depends on the presence of antitoxin in the blood stream, in response to clinical or subclinical disease or active immunization. Infants below 6 months of age carry IgG antibodies derived from the immune mother either transplacentally or through breast-feeding. Individuals who have fully recovered from diphtheria may continue to harbor the organisms in the throat or nose for weeks or even months. In the past, it was mainly through such healthy carriers that the disease was spread, and toxigenic bacteria were maintained in the population.
Clinical Symptoms
The clinical manifestations of diphtheria depend upon the following: (a) immune status of the patient, ( b) virulence of the bacteria, and (c) the site of the infection.
Respiratory diphtheria
The incubation period varies from 2 to 5 days. Characterized by the formation of a fibrinous pseudomembrane
on the palate, pharynx, epiglottis, larynx, or trachea
and may extend to the tracheobronchial tree. The pseudomembrane
is generally a firmly adherent, thick, fibrinous,
gray-brown membrane. Associated with marked edema of the tonsils, uvula,
submandibular region, and anterior neck.
Cutaneous diphtheria
Cutaneous diphtheria is generally caused by nontoxigenic
strains of C. diphtheriae. The condition is an
indolent nonprogressive infection characterized by a superficial,
nonhealing ulcer with a gray-brown membrane. Cutaneous diphtheria may persist for weeks
to months.

Diphtheria of other sites
Including the external ear, eye and
genital mucosa are the other sites where diphtheria lesions can occur. Rare sporadic
cases of endocarditis usually due to nontoxigenic strains. Septicemia caused by C. diphtheriae is rare but when it occurs, it is invariably fatal.
Treatment
Treatment should be started immediately after the clinical
diagnosis of diphtheria. Treatment of diphtheria is achieved through
1. Antitoxin therapy and
2. Antibiotics therapy
Vaccination is important, especially for high-risk groups
(such as children, elderly individuals, and immigrants from
areas of continued endemic infections).
Immunization by vaccination increases resistance to
C. diphtheriae infection.
DTP vaccines: It is typically combined with tetanus toxoid
and acellular pertussis (triple DTaP vaccine) and is the vaccine
of choice for children aged 6 weeks to 6 years
Other Corynebacteria species
1. Corynebacterium urealyticum: C. urealyticum is an important agent of urinary tract infection. These bacteria produce large quantities of the enzyme urease, which splits urea, producing ammonia, thereby making the urine alkaline. This leads to the formation of struvite calculi or stones.
2. Corynebacterium ulcerans: C. ulcerans usually causes skin infections but occasionally is associated with diphtheria-like lesions, such as pharyngitis and respiratory disease.
3. Corynebacterium haemolyticum: C. haemolyticum causes as many as 10% of all pharyngitis cases in patients between 10 and 30 years. The bacteria produce an extracellular toxin that causes an erythrogenic rash associated with the pharyngitis.
4. Corynebacterium pseudotuberculosis: C. pseudotuberculosis is closely related to C. diphtheriae and is also pathogenic for animals especially livestock. C. pseudotuberculosis is associated with both native and prosthetic valve endocarditis, pneumonia, lung abscesses, tracheobronchitis, and suppurative lymphadenitis. Antimicrobial resistance to antibiotics is also more common in isolates from immunosuppressed patients.
Bacillus
Bacillus includes rod-shaped Gram-positive
bacteria that form endospores. There are two main
groups of spore-forming bacteria:
1. Anaerobic spore-forming bacteria of the genus Clostridium
and
2. Aerobic or facultatively anaerobic spore-forming bacteria
of the genus Bacillus.
They are ubiquitous in soil, dust, air, and water. The genus Bacillus consists of more than 50 species. Bacillus anthracis (causes Anthrax) and Bacillus cereus (causes food poisoning) are the two most important species in humans and animals.
Bacillus anthracis
Humans and animals can be exposed to Bacillus anthracis organisms through inhalation, skin exposure, or by gastrointestinal (GI) absorption. B. anthracis was the first bacterium to be observed under a microscope. It was also the bacterium shown to be the cause of disease. It was from studies of anthrax that Koch developed the Koch's Principles/ postulates. It was the first organism to be isolated in pure culture and shown to form spores. The bacterium was also the first to be used by Louis Pasteur through attenuation to develop the first vaccine.
Morphology
B. anthracis is a Gram-positive spore-forming bacteria with very large cells measuring 1-1.2 m in width and
3-5 µm in length. In smears from infected tissues, the bacteria are found as single cells, cell pairs, and in short chains, the entire chain being
surrounded by a capsule. It is capsulated. The bacterium forms the capsule only when grown on nutrient agar containing 0.7% sodium bicarbonate
in the presence of 5-20% carbon dioxide.
Gram staining of B. anthracis shows the characteristic squared ends with spores as unstained spaces. Anthrax spores are oval, central in position, and are refractile. The spores are resistant to heat, cold, radiation, desiccation, and disinfectants. Spores are formed in culture or in soil under unfavorable conditions for growth. Anthrax spores need oxygen for sporulation. These germinate when exposed to a nutrient-rich condition, such as the tissues or blood of an animal or human host. Rainfall stimulates anthrax spore germination, while flies and vultures spread the spores.

The structure of B. anthracis colonies (Source: CDC)
Culture
The bacteria grow at a temperature range of 12-45oC, optimum temperature
being 37oC. They grow on a wide range of media including
ordinary nutrient media and several selective media. Some of the culture media include blood agar, gelatin medium. Knisely's Polymyxin B-lysozyme-EDTA-thallous acetate (PLET) agar medium is a selective medium used for isolation of B. anthracis from mixtures containing
other spore-bearing bacilli.
Biochemical tests
B. anthracis produces acid from glucose, maltose, sucrose, trehalose
and dextrin, but not from lactose, arabinose, D-xylose,
or D-mannitol. They are catalase positive and also reduce nitrate to nitrite.
The vegetative forms of the bacteria are susceptible to moist heat; they are killed at 60oC in 30 minutes. Bacillus spores are resistant to hostile physical and chemical conditions, ranging from desert sands and hot springs to Arctic soils and from fresh waters to marine sediments. They remain viable at temperatures, pH values, and salt concentrations at which few other organisms could survive. In the dry state and in certain soils, the spores may survive for 50 years or more. The spores are killed by moist heat at 100oC in 60 minutes. They are also killed by 4% (w/v) formaldehyde or 4% (w/v) potassium permanganate in a few minutes.
Antigenic properties
There are three types of antigens present in anthrax bacillus:
- Capsular antigen: Capsular antigen is present in virulent capsulated strains of B. anthracis. Antibodies against capsular antigen are not protective.
- Cell wall antigen: Present in the cell wall and is made up of N-acetylglucosamine and D-galactose.
- Somatic antigen: A heat-labile protein present in bacterial body. It stimulates immune system to produce antibodies, which are protective.
Virulence Factors
B. anthracis' virulence depends on the bacterial capsule and the anthrax toxin complex.
- Bacterial capsule
- Plays an important role in the pathogenesis of anthrax.
- Most important role during the establishment of infection
- Less important role during the terminal stages of the disease
- Anthrax toxin complex
- Protective antigen (PA) - is the binding domain of anthrax toxin and is necessary for entry of the bacteria into the host cell.
- Edema factor (EF) - This factor influences a cascade of signaling pahways that cause an increase in the cellular cAMP levels, leading to cellular edema within the target tissues.
- Lethal factor - Is a zinc metalloprotease that inactivates mitogen-activated protein kinase and other biochemical effects that result in sudden death.
Host Immunity
Anthrax is primarily a disease of animals. Herbivores (e.g., cattle, sheep, and horses) are very susceptible to the infection. Rats, chicken, pigs, cats, and dogs are quite resistant to the disease. Birds, buzzards, and vultures are naturally resistant to anthrax but may transmit the spores on their talons and beaks. Humans show intermediate susceptibility to B. anthracis.
In humans, anthrax can be of three types: (a) cutaneous
anthrax, (b) gastrointestinal anthrax, (c) inhalational anthrax,
and (d) anthrax meningitis.
Cutaneous anthrax is the most common form of anthrax and
constitutes more than 95% of the naturally occurring anthrax cases.
It is caused by the entry of spores through the skin
lacerations, abrasions; or through fly bites, usually on the face,
neck, or arms. This is commonly found in farmers and in persons
handling infected carcasses.
Gastrointestinal anthrax is caused by ingestion of undercooked meat
of infected carcasses containing spores. Abdominal pain and
fever are the first symptoms to appear approximately 2-5 days after the
ingestion of the food. These symptoms are followed by nausea,
vomiting, and diarrhea. Death occurs rapidly in patients that do not receive antibiotics. Mortality is very high and is always more than 50%.
Inhalational anthrax is also known as 'wool sorters disease'.
The condition occurs after inhaling spores into the lungs.
The spores are present in the dust or in the filaments of wool
from infected animals, particularly in wool factories. Spores
are ingested by alveolar macrophages and are carried to the
mediastinal lymph nodes. Anthrax in the lungs does not cause
pneumonia, but it does cause hemorrhagic mediastinitis and
pulmonary edema.
Anthrax meningitis may occur as a result of bacteremia
from the inhalational anthrax but is a less common
manifestation of the anthrax. Several large, encapsulated, Gram-positive
bacilli are observed in the CSF. Mortality may be as high as
100%.
Epidemiology
Anthrax has been reported worldwide, occurring in the soil in the form of extremely resistant spores. These spores cause infection in humans and in farm and wild animals that have grazed on contaminated land or ingested contaminated food.

An illustration of transmission of Anthrax. (Source: CDC)
Treatment
B. anthracis is generally sensitive to penicillins; therefore, penicillin G is the first-line treatment. Penicillin, such as amoxicillin or amoxicillin/clavulanic acid, is effective for the treatment of cutaneous anthrax.
Bacillus cereus
B. cereus is widely distributed in nature, such as soil, vegetables, milk, cereals, spices, meat, and poultry. It is the most important pathogen known to cause food poisoning. B. cereus food poisoning occur sporadically worldwide due to the ingestion of contaminated food in which bacteria have multiplied to high levels under conditions of improper storage after cooking. B. cereus is a spore-forming Gram-positive bacillus. It is generally motile, but nonmotile strains may also occur. It is a facultative anaerobe.
Culture
B. cereus is a nonfastidious bacterium that grows on ordinary media, such as nutrient agar. Mannitol, egg yolk, phenol red polymyxin agar (MYPA) is the selective media used for the isolation of B. cereus from feces and other sources. B. cereus ferments glucose, but not mannitol, and produces the enzyme lecithinase. B. cereus spores can survive in the soil over a long periods of time. B. cereus produces many heat-labile and heat-stable toxins and enzymes, which are responsible for many disease conditions. The heat-labile enterotoxin is similar to the enterotoxins produced by Vibrio cholerae and Escherichia coli. This toxin causes diarrhea as a symptom of B. cereus food poisoning. B. cereus also produces at least three other toxins (a) cerolysin (b) necrotic toxin and (c) phospholipase C.
Septicemia and endocarditis are the other infections caused by B. cereus in immunocompromised patients.
Clostridium
The genus Clostridium consists of Gram-positive, anaerobic bacilli capable of forming endospores. The endospores typically are wider than the bodies of the bacilli, giving the bacteria a swollen appearance resembling a spindle.

Clostridium showing endospores. (Source: CDC)
General Properties of Clostridia
Most species are anaerobic but few species such as Clostridium
tertium, Clostridium histolyticum, etc. are aerotolerant i.e., can grow on agar even in presence of air.
Clostridia are rod-shaped bacilli measuring 3-8 X 0.4-1.2 µm
in size.
The bacilli are highly pleomorphic and show long filaments
and involution forms.
They are Gram-positive but old cultures may appear Gramvariable
and even Gram-negative.
Most Clostridium species with few exceptions (e.g., Clostridium
perfringens, Clostridium tetani type VI) are motile due to the
presence of peritrichous flagella.
Sporulation takes place in the environment and also inside animal bodies, but not in humans. The shape and location of the spores in the bacteria vary in different clostridial species but the most common spore locations include Central spores, Subterminal spores, Oval terminal spores and Spherical terminal spores.
Clostridium perfringens
C. perfringens is the most important Clostridium species. It causes gas gangrene, which is a severe life-threatening disease. The bacteria can also cause necrotic enteritis and food poisoning.
Morphology
C. perfringens is a large, rectangular, Gram-positive bacillus
measuring 4 - 6 µm in length; it is a straight bacillus with
parallel sides and round and truncated ends.
They occur as single cells, chains of cells or bundles. They are capsulated and nonmotile. They possess central or subterminal spores. These spores are rarely observed in clinical specimens
Culture
C. perfringens is an anaerobic but aerotolerant bacterium. The bacteria can grow under microaerophilic conditions and cells do not die on exposure to air. They grow at a temperature range of 20-44oC (optimum temperature 37oC) and a pH range of 5.5-8.0.
C. perfringens ferments glucose, lactose, sucrose, and maltose with the production of acid and gas. They produce H2S and reduce nitrate to nitrite.
C. perfringens spores are killed within 5 minutes by boiling, but spores of certain strains are killed by boiling for a longer period of 1-3 hours
C. perfringens spores are resistant to commonly used antiseptics and disinfectants. The bacilli are sensitive to metronidazole and penicillins.
Gas Gangrene
Gas gangrene or clostridial myonecrosis is a serious and life-threatening condition. The incubation period is variable. It may be as short as 7 days or as long as 6 weeks after clostridia are introduced into the tissue by trauma or surgery. The onset of the disease is rapid and is associated with increasing pain, tenderness, and edema of the affected part and systemic signs of toxemia. Accumulation of gas in the tissues-caused by metabolic activity of the rapidly dividing clostridia - is characteristic of the disease, thus the name gas gangrene. In untreated cases, the condition progresses very fast with extensive muscle necrosis, shock, renal failure, and even death within 48 hours of onset of the disease.
Clostridial Food Poisoning
Food poisoning is caused by ingestion of cold and warmed up meat dishes contaminated with large numbers (108-109) of C. perfringens type A strains. The incubation period is short, between 8 and 24 hours. The most common signs are abdominal cramps and watery diarrhea. There is no nausea, vomiting, or fever. The disease is self-limiting and recovery occurs within 24-48 hours.
Diagnosis
Gram staining of smears is a useful method in diagnosis of
C. perfringens infection. It provides information regarding the
species of clostridia that causes the infection and also indicates
relative number of the clostridial species found in clinical
specimens.
Culture of samples and incubation in aerobic and anaerobic conditions. C. perfringens grows very rapidly and colonies can be demonstrated on the media after a few hours of incubation.
Serodiagnosis based on an enzyme immunoassay to detect enterotoxin in feces was recently developed for diagnosis of food poisoning.
Clostridium tetani
C. tetani is the causative agent of Tetanus. It is an obligate anaerobic Gram-positive bacillus. Tetanus is an infectious disorder characterized by increased muscle tone and spasms caused by the release of a neurotoxin, tetanospasmin.
Morphology
C. tetani is a slender, Gram-positive bacillus measuring 4-8 µm in length. Young cultures are usually Gram-positive but old cultures are Gram- variable and may even be Gram-negative. C. tetani are capsulated. All strains of C. tetani except type VI are motile by the presence of flagella. Type VI strain bacilli do not have any flagella, hence are non-motile.
Culture
C. tetani are obligate anaerobes. They are extremely sensitive to oxygen, so can grow only in the absence of oxygen. The bacillus grows at an optimum temperature of 37oC and at pH of 7.4. They can grow on ordinary media and on media enriched with serum and blood.
Biochemical Reactions
Biochemical reactions C. tetani shows following reactions:
C. tetani has mild proteolytic activity but completely lacks
saccharolytic activity.
C. tetani does not ferment any sugars. It does not produce H2S and
does not reduce nitrates.
It is indole positive, but MR and VP negative. It produces a greenish fluorescence on MacConkey medium, which contains neutral red.
C. tetani spores of different strains show a variable heat resistance. Most spores are killed by boiling at 100oC for 10-15 minutes and by autoclaving at 121oC for 20 minutes. They are also killed by 1% aqueous solution of iodine and 10% of hydrogen peroxide. The spores are resistant to most antiseptics.
Typing: C. tetani are classified into 10 serological types (types I to X) based on agglutination. All strains produce the same toxin. The toxin is neutralized by the standard antitoxin.
Pathogenesis and Immunity
C. tetani produces the following toxins: (a) tetanolysin, (b) tetanospasmin, and (c) neurotoxin or nonspasmogenic toxin.
Tetanospasmin is a potent heat labile toxin. It prevents the release of neurotransmitters (e.g., GABA, glycine, etc.), hence blocks specific synaptic inhibition in the spinal cord. Motor neurons are left under no inhibitory control and undergo sustained excitatory stimulation.
Tetanolysin is a heat stable hemolysin. Its significance in the pathogenesis of tetanus is unknown.
Neurotoxin is also a neurotoxin, however, its significance in Tetanus remains unknown.
Pathogenesis of Tetanus
Tetanus is caused by entry of the C. tetani spores. Under anaerobic conditions, the spores germinate to vegetative form and subsequently produce toxins. The conditions that favor spore germination in tissues include wounds with dead devitalized tissue or a foreign body, or active infection. Tetanospasmin is absorbed locally and at the nervous system and is transferred centripetally into neurons of the CNS.
Generalized tetanus is the most common form of tetanus. It occurs when the toxin produced at the wound site spreads through the lymphatics and blood to multiple nerve terminals. This is because the blood-brain barrier prevents direct entry of toxin to the CNS. The incubation period varies from 7 to 21 days and depends on the distance of the site of wound from the CNS.
Tetanus is also called 'lock jaw' and is due to involvement of masseter muscle and is the most common and early sign of the disease. Difficulty in swallowing, irritability, and restlessness are the other early signs. As the condition progresses, patients have generalized muscle rigidity with intermittent reflex spasms in response to stimuli, such as noise or touch. Tonic contractions cause opisthotonus, a condition characterized by flexion and adduction of the arms, clenching of the fists, and extension of the lower extremities. During these episodes, patients feel severe pain. The spasms can cause fractures, tendon ruptures, and acute respiratory failure.

Immunity
The host's immunity is mostly mediated by specific antibodies produced against tetanus toxin. Antibodies specifically combine with free toxin and prevent the action of the toxin.
Pathogen Habitat
C. tetani organisms are found in soil, in animal feces, and, occasionally, in human feces as well as on inanimate objects. The spores may survive for years in some environments and are resistant to disinfectants and even to boiling for 20 minutes.
Some types of wounds are more susceptible to tetanus, for example; grossly contaminated wounds, wounds exposed to saliva or feces, deep wounds, avulsions, punctures, or crush injuries.
Diagnosis
Microscopy: Gram staining of smears for C. tetani is useful but frequently unsuccessful and also unreliable.
Culture: Samples are inoculated on a blood agar and incubated anaerobically for 24-48 hours. C. tetani produces swarming growth, which spreads throughout the plate
Serological tests are not used because neither antibodies to tetanus toxin nor the tetanus toxin are detectable in serum of patients.
The spatula test is the most useful test and it can be performedon the bedside. This test is based on touching the oropharynx with a spatula or tongue blade. This touch typically elicits a gag reflex and the patient tries to expel the spatula (negative test for tetanus). If tetanus is present, patients develop a reflex spasm of the masseters and bite the spatula (positive test). The test is 100% specific and 94% sensitive.
Treatment
Treatment of tetanus involves (a) initial supportive therapy, (b) wound debridement and care, (c) stopping toxin production, (d) neutralizing unbound toxin, (e) controlling disease manifestations, and (f) managing complications. It includes antibiotics therapy and human immunoglobulin therapy.
Vaccination
Vaccination with tetanus toxoid is the key to preventing tetanus. Vaccination is carried out by toxoids, which are available either as plain toxoid or adsorbed on aluminum hydroxide or phosphate. The toxoid is given alone or in combination with diphtheria toxoid and acellular pertussis (whooping cough) (DTaP or triple) vaccine.
Clostridium botulinum
C. botulinum is a group of Gram-positive, spore- forming, non-capsulated, anaerobic bacteria which causes botulism. Older cultures may seem to be Gram negative.
Culture
C. botulinum is a strict anaerobe and grows at an optimum temperature of 35oC. The bacteria can grow on a wide range of media including blood agar, Mueller-Hinton agar, and RCM media. On blood agar, C. botulinum produces large, irregular, and semitransparent colonies with irregular fimbriate border. Spores are produced when grown in alkaline glucose gelatin media at 20-25oC.
Biochemical Tests
C. botulinum is identified by its ability to ferment glucose, hydrolyze gelatin, digest protein, and produce the enzyme lipase.
Production of enzyme lipase can be demonstrated by formation of iridescent film on C. botulinum colonies grown on egg yolk agar.
C. botulinum organisms as well as spores are highly resistant. They resist boiling at 100oC for several hours, but are killed by pressure cooking at 120oC for 10 minutes.
Pathogenicity and Immunity
They cause disease primarily by production of an exotoxin, the botulinum toxin, which is the major virulence factor of the bacteria
The botulinum toxin differs from other exotoxins in that it is produced only on death and autolysis of the bacteria, but not when the bacilli are alive.
The botulinum toxin is the most potent naturally occurring toxin known to mankind. The lethal dose for mice is 0.000,000,033 mg and for human beings is 1-2 g.
Pathogenesis
Botulism can be caused in various ways:
Food-borne botulism is caused by ingestion of botulinum
toxin present in contaminated food.
Infant botulism is caused by toxins produced by C. botulinum
present in the intestine.
Wound botulism is caused by toxins produced in a C. botulinum
contaminated wound.
The toxin enters the vascular system and is transported to peripheral cholinergic nerve terminals, such as neuromuscular junctions, cholinergic parasympathetic nerve endings, and some peripheral ganglia. The toxin binds to receptor sites on presynaptic motor nerve terminals and causes blockade of neuromuscular conduction. The botulinum toxin results in hypotonia, manifesting as descending symmetric flaccid paralysis of the respiratory muscles.
Food-borne Botulism
Food poisoning occurs on ingestion of preformed toxins in food contaminated with C. botulinum. The severity of illness varies from a mild to a very serious disease resulting in death within 24 hours. The incubation period is short, varies from 12 to 36 hours after ingestion of the contaminated food. Vomiting, nausea, dry mouth, constipation, abdominal pain, blurred vision with fixed dilated pupils are the initial signs. Fever, typically is absent. Death is due to respiratory paralysis and occurs in 1-7 days after onset of the disease.
Infant Botulism
Unlike food poisoning, imfant botulism is caused by neurotoxins produced in vivo by C. botulinum that have colonized the gastrointestinal tract of the infants.
Wound Botulism
Occurs following heavy contamination of wounds with soil or water containing C. botulinum spores.
Habitat
C. botulinum is ubiquitous. It is found in soil and water worldwide. Spores of C. botulinum are distributed widely in the soil and have been found throughout the world.
Laboratory Diagnosis
Diagnosis of food-borne botulism is made by
demonstration of C. botulinum in food by culture and by
demonstration of toxin in food or feces.
Diagnosis of infant botulism is confirmed by isolation of
bacilli and detection of botulinum toxin in feces of the
patient.
Diagnosis of wound botulism is made by isolation of or
by detection of toxin of botulinum in wound pus and
exudates.
Microscopy: Gram staining of the smears made from food and other specimens may show Gram-positive spore-bearing C. botulinum.
C. botulinum toxin can be demonstrated in foods, feces, and other specimens by serum toxin bioassay, enzyme-linked immunosorbent assay, and polymerase chain reaction.
Treatment
Treatment of botulism involves (a) initial supportive therapy, (b) neutralizing unbound toxin by specific antitoxins, and (c) stopping toxin production by use of antibiotics.
Prevention and Control
Food-borne botulism is best prevented by high-temperature pressure cooking, which kills spore present in fruits and vegetables. Storing the food in refrigerator at 4oC or in an acidic pH prevents germination of spores, if present, to vegetative bacterial form. Strict adherence to recommended home-canning techniques is essential. Wound botulism is prevented by immediate and a thorough debridement of contaminated wounds. Cessation of drug use by drug addicts prevents wound botulism due to intravenous drug abuse. Infant botulism is prevented by avoiding administration of honey to infants.
Nonsporing Anaerobes - Gram-Positive Bacilli
Propionibacterium: Propionibacterium acnes and Propionibacterium propionicus are two important species of clinical importance. P. acne is the most common causative agent of acne in teenagers and young adults.
Mobiluncus: They are found as part of the normal flora of the genitourinary tract. In women with bacterial vaginitis, they are found in very high numbers. Typical Gram-staining features of the bacteria are diagnostic. They are sensitive to erythromycin, ampicillin, but resistant to colistin.
Bifidobacterium and Eubacterium: Bifidobacterium spp. and Eubacterium spp. are commonly found in the oropharynx, large intestine, and vagina. They are usually isolated as contaminants. Repeated isolation of these bacteria in absence of other pathogens may suggest their role as possible agents of infection.
Lactobacillus: They are commonly found in the mouth, stomach, and intestine and in the adult vagina. They are commonly isolated in blood and urine cultures. The presence of lactobacilli even in high numbers in urine culture usually represents contamination of bacteria from the urethra, in which lactobacillus are most commonly present. Lactobacilli usually do not cause infection of the urinary tract, because they fail to grow in the urine.
Anaerobic Gram-Negative Bacilli
Gram-negative anaerobes, such as Fusobacterium spp., Prevotella spp., Porphyromonas spp., and non-B. fragilis spp. cause up to 50% of chronic infections of the sinuses and ears; and most of periodontal infections.
Most of the B. fragilis, Prevotella, and Porphyromonas species are resistant to penicillins and to many cephalosporins due to production of beta-lactamase. The resistance is overcome by treating with high concentration of carbenicillin, piperacillin, imipenem along with beta-lactamase inhibitors. Bacteroides show plasmid-mediated resistance to clindamycin.
Coliforms
Coliform bacteria are defined as Rod shaped Gram-negative non-spore forming and motile or non-motile bacteria which can ferment lactose with the production of acid and gas when incubated at 35-37 oC. Due to the limited ability of certain coliform bacteria to ferment lactose, the definition has changed to bacteria containing the enzyme Beta-galactosidase. They are a commonly used indicator of sanitary quality of foods and water. Coliforms can be found in the aquatic environment, in soil and on vegetation; they are universally present in large numbers in the feces of warm-blooded animals. While coliforms themselves are not normally causes of serious illness, they are easy to culture, and their presence is used to indicate that other pathogenic organisms of fecal origin may be present.
Typical genera of coliforms include:
Citrobacter
Enterobacter
Hafnia
Klebsiella
Escherichia
Escherichia

SEM micrograph of cluster of Escherichia coli. (Source: USDA)
Escherichia are animal and human intestinal pathogens. The genus Escherichia consists of five species: E. coli, Escherichia fergusonii, Escherichia hermanii, Escherichia vulneris, and Escherichia blattae. Of these species, E. coli is the most common and most important species causing infection in humans. E. coli is further subdivided into biotypes and serotypes based on O, H, and K antigens.
Escherichia coli (E. coli)
E. coli has been recognized as harmless commensal and also as a versatile pathogen. E. coli in humans causes a broad spectrum of diseases. It is an important cause of enteric illness, urinary tract infection (UTI), neonatal sepsis, and neonatal meningitis. Hemolytic uremic syndrome (HUS) is a serious complication of enteric infection with certain E. coli strains.
Morphology
E. coli is a Gram-negative bacillus, which measures around 1-3 X 0.4-0.7 µm in size. The bacilli are arranged singly or in pairs. They are motile due to the presence of peritrichous flagella, though some strains are nonmotile. Some strains of E. coli may be fimbriated.
The genus is named after Theodor Escherich, the discoverer of Escherichia coli.
Culture
Escherichia are facultative aerobes, with both aerobic and anaerobic growth, and an optimum temperature of 37oC and a pH of 7.2. The bacteria grow on a wide range of media including Mueller-Hinton agar, nutrient agar, blood agar, and MacConkey agar. Primary isolation can be made on nutrient agar and blood agar.
Biochemical reactions
E. coli ferments lactose, glucose, mannitol, maltose, and many other sugars with the production of acid and gas. They do not ferment sucrose. They do not liquefy gelatin, do not produce hydrogen sulfide (H2S), or do not utilize urea. The indole, methyl red (MR), Voges-Proskauer (VP), and citrate utilization tests, generally referred to as the IMViC tests, are four important biochemical tests widely used in the classification of enterobacteria. E. coli is inhibited by the presence of 7% sodium chloride in salt media used for isolation of staphylococci.
Pathogenesis
While many Escherichia are commensal members of the gut microbiota, certain strains of some species, most notably the serotypes of E. coli, are human pathogens, and are the most common cause of urinary tract infections, significant sources of gastrointestinal disease, ranging from simple diarrhea to dysentery-like conditions, as well as a wide range of other pathogenic states classifiable in general as colonic escherichiosis.
Some of the virulanece factors in E. coli include:
- Fimbriae - adherence of bacteria to gastrointestinal tract; of importance in urinary tract infections; and cause mannose-resistant hemagglutination.
- Endotoxin - causes systemic manifestations of endotoxic shock, and protect the bacteria from phagocytosis and from the bactericidal effects of complement reaction.
- Capsule - antiphagocytosis protects Escherichia coli from phagocytosis. Protect the organism from serum killing.
- Sequestration of growth factors: The capability of Escherichia coli to compete for nutrients in host cells.
- Adhesins Adhesins facilitate firm adhesion of E. coli to the gastrointestinal or urinary tract mucosa, thereby preventing the bacteria being eliminated by the flushing action of voided urine or intestinal motility.
- Hemolysins (HlyA) Important in the pathogenesis of disease caused by uropathogenic strains of Escherichia coli.
- Shiga toxins - are cytotoxins named due to their similarities with Shigella dysenteriae type 1 toxin.
- Heat stable toxin, causes increased secretion of fluids
- Heat labile toxin Watery diarrhea due to hypersecretion of fluid into the lumen of the gut.
- Siderophores Removes iron from mammalian iron transport proteins like transferring and lactoferrin.
Enterotoxins
Urinary tract infections: E. coli serotypes that are normally found in the feces are commonly responsible for urinary tract infections. UTI is an ascending infection in which the bacteria that originate from the intestinal tract contaminate the urethra, ascend into the bladder, and may spread to the kidney or prostate.
Gastroenteritis: Gastroenteritis is caused by exogenous infections acquired from water, food, or vegetables contaminated with fecal E. coli. The strains of E. coli that cause gastroenteritis are classified into the following six groups: (a) enteropathogenic E. coli (EPEC), (b) enterotoxigenic E. coli (ETEC), (c) enteroinvasive E. coli (EIEC), (d) enterohemorrhagic E. coli (EHEC), (e) enteroaggregative E. coli (EAEC), and (f) diffusely adherent E. coli (DAEC)
Epidemiology
Many strains of diarrheagenic E. coli primarily affect populations in developing countries. There is a wide variation in the prevalence of these strains worldwide. EPEC, EAEC, and DAEC have been reported to occur most often in developing countries. ETEC is the primary cause of traveler's diarrhea and is the major cause of infantile diarrhea in poor and developing countries. ETEC causes nearly more than 600 million cases of diarrhea every year and 700,000 deaths in children below 5 years. EHEC is an emerging cause of food-borne disease, particularly in the northern United States and Canada. Outbreaks of HUS in children that caused fatalities have also been documented in these countries.
Diagnosis
Laboratory diagnosis of E. coli infections is based on:
1. Isolation of E. coli by culture.
2. Demonstration of toxins of diarrheagenic E. coli.
Treatment
E. coli isolated from community-acquired infections are usually sensitive to commonly used antibiotics except penicillins. Hospital-acquired E. coli isolates, however, show multidrug resistance. Majority of E. coli infections are best treated based on antibiotics susceptibility testing results.
Prevention and Control
Availability of safe drinking water, proper food hygiene, and sanitary disposal of excreta are the most cost-effective strategies for reducing the incidence of enteric infections caused by E. coli. Cooking ground beef thoroughly is the most effective way to prevent hemorrhagic colitis caused by E. coli O157:H7.
Klebsiella
The bacteria are named after Edwin Klebs, who demonstrated the bacteria for the first time. Members of the genus Klebsiella are Gram-negative, rodshaped, nonmotile bacteria, with a prominent polysaccharide capsule. Klebsielleae organisms are emerging as important agents of nosocomial infections. K. pneumoniae is the most important species of the group to cause infections in humans.
Klebsiella pneumoniae
K. pneumoniae are Gram-negative, short and straight rods measuring about 1-2 X 0.5-0.8 µm in size. They are nonmotile and nonsporing. They are arranged singly or in pairs. Freshly isolated strains show a well-defined polysaccharide capsule. They are lactose-fermenting, urease- positive, and indole-negative organisms. They produce lactose-fermenting red colonies on MacConkey agar. Capsule is the main virulence factor. The capsule prevents the bacteria from phagocytosis by polymorphonuclear granulocytes. The capsule also prevents bacterial death
Citrobacter
Citrobacter is a normal inhabitant of the intestine of humans. They grow well on nutrient agar and other ordinary media producing smooth and convex colonies. The colonies are not pigmented. On MacConkey and DCA media, they produce pale colonies. Citrobacter spp. are motile, H2S positive, MR positive, citrate positive, and indole variable. They do not decarboxylate lysine, but most strains decarboxylate ornithine. They show extensive antigenic sharing with salmonellae, hence may be mistaken for salmonellae.
Edwardsiella
The genus Edwardsiella differs from the genus Escherichia by its ability to produce hydrogen sulfide. The genus Edwardsiella includes Edwardsiella tarda, the only pathogenic species for humans. E. tarda inhabits the intestines of snakes and other cold-blooded animals. E. tarda is an occasional human pathogen isolated from wounds, blood, and CSF in cases of fatal meningitis. The bacteria have also been isolated from stool of normal healthy people and that of patients with diarrhea.
Enterobacter
The genus Enterobacter includes 12 species, of which Enterobacter cloacae and Enterobacter aerogenes, followed by Enterobacter sakazakii are the most frequently isolated species causing human infections. Enterobacter are Gram-negative bacilli, which belong to the tribe Klebsielleae, and are aerobic and facultatively anaerobic. On sheep blood agar, Enterobacter produces large, gray, and dry or mucoid colonies; on MacConkey agar, lactose-fermenting pink colonies. The bacteria ferment glucose with production of acid. They differ from Klebsiella by being motile, ureasenegative, and ornithine decarboxylase-positive.
Enterobacter species rarely cause disease in otherwise healthy people. These are opportunistic pathogens. The patients who stay in hospital, especially in the ICU, for prolonged periods are at high risk to aquire Enterobacter infections.
Hafnia
Hafnia alvei is the only species of the genus Hafnia. It is found in human and animal feces, sewage, soil, and water. H. alvei is motile. It does not ferment lactose, raffinose, sucrose, adonitol dulcitol, and inositol. It is indole and MR negative, and VP and citrate positive. The bacteria have been isolated from abscesses, wounds, sputum, urine, blood, and from other sites, but often with other bacteria.
Salmonella
Salmonella is a genus of rod-shaped (bacillus) Gram-negative bacteria of the family Enterobacteriaceae. The two species of Salmonella are Salmonella enterica and Salmonella bongori. Salmonella was named after Daniel Elmer Salmon, an American veterinary surgeon (1850-1914).
Salmonella species are non-spore-forming, predominantly motile enterobacteria with cell diameters between about 0.7 and 1.5 µm, lengths from 2 to 5 µm, and peritrichous flagella.

Culture
Depending on the environmental conditions, Salmonella spp can be chemotrophs, (obtaining their energy from oxidation and reduction reactions using organic sources), facultative anaerobes, (capable of generating ATP with oxygen ("aerobically") when it is available), or using other electron acceptors or fermentation ("anaerobically") when oxygen is not available.
They grow at an optimum temperature of 37oC in a pH of 6-8 on a variety of nonselective (Mueller-Hinton agar) and selective (Wilson and Blair's bismuth sulfite medium) media.
Biochemical Reactions
Salmonellae show following reactions:
- They ferment glucose, mannitol, and maltose, forming acid and gas. S. Typhi is an exception, which does not ferment the sugars.
- They do not ferment lactose, sucrose, or salicin.
- They do not produce indole.
- Most salmonellae except S. Paratyphi A, S. Choleraesuis, and some other species produce H2S.
- They do not hydrolyze urea. They are MR positive and VP negative and citrate positive.
The bacilli are killed at a temperature of 55oC in 1 hour or at 60oC in 15 minutes. They are also killed by 0.2% mercuric chloride or 5% phenol in 5 minutes. Boiling, chlorination of water, and pasteurization of milk kill the bacteria.
Pathogenesis and Immunity
Salmonella possess three major antigens:
1. H or flagellar antigen: This antigen is present on the flagella
and is heat and alcohol labile.
2. O or somatic antigen: O antigens occur on the surface of
the outer membranes and are determined by specific sugar
sequences on the cell surface.
3. Surface antigens (Vi antigen, M and N antigen, and F antigens)
Salmonella spp are intracellular pathogens. Most infections are due to ingestion of food contaminated by animal feces, or by human feces, such as by a food-service worker at a commercial eatery. Individuals with depressed CMI appear to be more susceptible to S. Typhi infections. In acute infection, O antibody appears first, rising progressively, later falling, and often disappearing within a few months; H antibody appears slightly later but persists longer. Rising or high O antibody titers generally indicate acute infection, whereas elevated levels of H antibody help to identify the type of enteric fever.
The severity of disease in individuals infected with salmonellae is dependent on the virulence factors of the infecting strain as well as on the human host. Salmonella serotypes can be divided into two main groups-typhoidal and nontyphoidal. On reaching the intestine, the salmonellae attach themselves by fimbriae or pili to cells lining the ileal mucosa.
Typhoidal serotypes can only be transferred from human-to-human, and can cause food-borne infection, typhoid fever, and paratyphoid fever. Typhoid fever is caused by Salmonella invading the bloodstream (the typhoidal form), or in addition spreading throughout the body, invading organs, and secreting endotoxins (the septic form). This can lead to life-threatening hypovolemic shock and septic shock, and requires intensive care including antibiotics. Nontyphoidal serotypes can be transferred from animal-to-human and from human-to-human. They usually invade only the gastrointestinal tract and cause salmonellosis, the symptoms of which can be resolved without antibiotics. However, in sub-Saharan Africa, nontyphoidal Salmonella can be invasive and cause paratyphoid fever, which requires immediate treatment with antibiotics.
Because Salmonella are intracellular, cell mediated immunity (CMI) rather than humoral antibodies play more important role in protection against the disease.
A summary of diseases caused by Salmonella species is shown below:
| Salmonella species | Disease/syndrome |
|---|---|
| Salmonella Typhi | Typhoid fever |
| Salmonella Paratyphi | Paratyphoid fever |
| Salmonella Cholerasuis | Salmonella bacteremia |
| Salmonella Typhimurium | Salmonella gastroenteritis |
| Salmonella Enteritidis | Salmonella gastroenteritis |
| Salmonella Hadar | Salmonella gastroenteritis |
| Salmonella Heidelberg | Salmonella gastroenteritis |
| Salmonella Agona | Salmonella gastroenteritis |
| Salmonella Virchow | Salmonella gastroenteritis |
| Salmonella Seftenberg | Salmonella gastroenteritis |
| Salmonella Indiana | Salmonella gastroenteritis |
| Salmonella Newport | Salmonella gastroenteritis |
| Salmonella Anatum | Salmonella gastroenteritis |
S. Typhi is an invasive bacterium. It colonizes the human intestine and, under specific conditions, directly invades the intestinal mucosa or multiplies for several days within the mononuclear phagocytic cells in the liver, spleen, lymph nodes, and Peyer patches of the ileum before invasion.
Epidemiology
Enteric fever is endemic in many developing countries especially where sanitary conditions are poor. Typhoid fevers are endemic in the India, Southeast and Far East Asia, the Middle East, Africa, Central America, and South America. Approximately, 12-13 million cases of typhoid fever occur globally each year with 600,000 deaths. S. Paratyphi A is prevalent in India and other Asian countries, Eastern Europe, and South America; S. Paratyphi B in North America, Britain, and Western Europe; and S. Paratyphi C in Eastern Europe and Guyana.
S. Typhi and S. Paratyphi (A, B, and C) are strict human pathogens. They are not found in any other animal hosts. S. Typhimurium have a wide host range affecting animals, birds, and humans, while Salmonella Abortus-equi is found only in horses, Salmonella Abortus-oris in sheep, and S. Gallinarum in poultry.
Poultry, livestock, reptiles, and pets are the principal reservoirs for nontyphoidal Salmonella organisms. Ingestion of improperly cooked fruits, vegetables, foods of animal origin, including poultry, red meats, unpasteurized milk, and eggs that have been contaminated by infected animals or an infected human is the mode of transmission. Contact with infected reptiles, such as iguanas, pet turtles, and tortoises, and ingestion of contaminated water are some of the modes of transmission.
Laboratory Diagnosis
Diagnosis of enteric fever is based on the following
methods:
1. Isolation of Salmonella spp. by culture,
2. Serodiagnosis is based on detection of specific
Salmonella antibodies in the serum, or antigen in the serum and
also in urine by various serological tests, and
3. Molecular diagnosis by DNA probes and PCR.
Blood, blood clot, bone marrow, and stool are common specimens used for isolation of typhoidal bacilli for culture.
Treatment
Chloramphenicol was the antibiotic of choice for treatment of enteric fever since its introduction in 1948
Prevention and Control
Availability of safe drinking water, proper food hygiene, and sanitary disposal of excreta are the most cost-effective strategies for reducing the incidence of typhoid fever in endemic countries.
Immunization with typhoid vaccines at regular intervals also considerably reduces the incidence of typhoidal Salmonella infections.
Salmonella Gastroenteritis
Salmonella gastroenteritis is the most common form of salmonellosis. Salmonella gastroenteritis or food poisoning is generally a zoonotic disease, caused by certain species of nontyphoidal salmonellae, which are primarily animal pathogens. Some other common species include S. Enteritidis, Salmonella Hadar, Salmonella Heidelberg, S. Agona, Salmonella Virchow, Salmonella Seftenberg, Salmonella Indiana, Salmonella Newport, and S. Anatum. Human infection usually occurs by consumption of contaminated foods. The most common sources of salmonellae are milk and milk products, meat, poultry, and eggs. Of great concern are eggs and egg products.
Salmonella Bacteremia
All Salmonella spp. can cause bacteremia. However, S. Choleraesuis, S. Paratyphi, and S. Typhi more commonly cause a bacteremic disease. Pediatric and geriatric patients as well as patients with AIDS are increasingly susceptible to suffer from Salmonella bacteremia. Localized suppurative infections, such as osteomyelitis, deep abscesses, endocarditis, arthritis, and meningitis can occur in as many as 10% of patients. The case fatality may be as high as 25%.
Shigella
Shigella is the most common cause of bacillary dysentery, which occurs worldwide. The disease is spread through fecal–oral transmission, and humans are the only natural reservoir of the bacteria.
Based on a combination of biochemical and serological characteristics, shigellae are classified into four species or subgroups, consisting of more than 45 O antigen-based serogroups.
- Shigella dysenteriae (group A)
- Shigella flexneri (group B)
- Shigella boydii (group C)
- Shigella sonnei (group D)
Morphology
Shigella shows following features:
- Shigella are short, Gram-negative rods, about 0.5 X 1-3 µm in size.
- They are nonmotile, nonsporing, and noncapsulated.
- With the exceptions of S. flexneri, serotype 6, Shigella species and some strains of other serotypes possess fimbriae.

Shigella
Culture
Shigella are aerobes and facultative anaerobes. They grow at a temperature range of 10-40oC with an optimum temperature of 37oC and pH 7.4.
They grow on ordinary media, such as nutrient agar or Mueller-Hinton agar. Shigella colonies on nutrient agar, after overnight incubation, are small, circular, convex, smooth, and translucent. Occasionally on primary isolation and frequently in subcultures, a proportion of the colonies may be of the rough type.
Shigella also ferments glucose, producing acid but without gas.
Biochemical Tests
Shigella ferments glucose, producing acid but without gas.
Shigella ferments mannitol, forming acid but no gas.
They do not ferment lactose, sucrose, salicin, adonitol, or inositol. However, S. sonnei ferments lactose and sucrose late.
They reduce nitrates to nitrites and do not form H2S. They are MR positive, citrate negative, and oxidase negative
Shigellae are killed at a temperature of 55oC in 1 hour or by 1% phenol in 30 minutes. In feces, they die within a few hours due to acidity produced by the growth of intestinal bacteria. They remain viable in moist environments for days, but die on drying.
Pathogenesis and Immunity
The antigenic structure of shigellae is simple, unlike the complex antigenic structure of salmonellae. Shigellae possess somatic O antigens and certain strains possess K antigens.
Virulence in Shigella species involves both chromosomal- and plasmid-coded genes, which express for many virulence factors.
Endotoxins: The lipopolysaccharide (LPS) moiety functions as an endotoxin and is an important component of the virulence of the bacteria. The toxin helps in invasion, multiplication, and resistance of Shigella to phagocytosis by tissue macrophages.
Intestinal adherence factor: This mediates colonization of Shigella spp. in infected human hosts and in animal models. Shiga toxin: Shiga toxin is an exotoxin produced by S. dysenteriae. It is a heat-labile protein and acts as enterotoxin and neurotoxin.
Shigella spp. produce a serious disease known as bacillary dysentery. Infection occurs by ingestion. Shigella spp. cause disease by invading and replicating in cells lining the intestinal mucosa of the colon and multiply inside them. Subsequently, bacteria spread laterally to involve adjacent cells and penetrate into the lamina propria.
Shigella spp. cause shigellosis, a clinical syndrome encompassing the whole spectrum of disease caused by the bacteria. Bacillary dysentery is a severe clinical form of the shigellosis.
Epidemiology
Shigella species are strict human pathogens. They are found in the large intestine of infected human hosts. They are not found in any other animal hosts. Shigellosis is primarily a disease of children. Nearly, 70% of all infections occur in children younger than 15 years.
Shigellosis occurs worldwide. Estimated 150 million cases occur annually worldwide. The incidence of shigellosis in developing countries is nearly 20 times more than in developed countries.
It is estimated that 30% of these infections are caused by S. dysenteriae. S. flexneri is the most common cause of shigellosis in developing countries. S. sonnei is the most common cause in the industrial world.
Laboratory Diagnosis
Stool is the specimen of choice. Diagnosis of shigellosis is made by isolating Shigella spp. from feces.
Routine microscopy of stool may reveal clumps of polymorphonuclear leukocytes.
Serological tests are not useful in the diagnosis of shigellosis.
Treatment
Uncomplicated shigellosis is a self-limited condition and patients usually recover spontaneously in a few days. Hence, no antibiotics are recommended for these cases.
Prevention and Control
Therefore, control consists essentially in improving personal and environmental sanitation. Antibiotics are not used in prophylaxis. No effective vaccine is available.
Yersinia
Yersinia pestis is the most important species that causes plague, an acute and contagious, febrile illness transmitted to humans by the bite of an infected rat flea. Yersinia enterocolitica is other species, which causes mesenteric lymphadenitis especially in children. Yersinia pseudotuberculosis causes mesenteric adenitis.
Yersinia Pestis
Yersinia pestis causes Plague one of the most devastating diseases in history. Plague has caused large-scale epidemics, thereby changing the course of history in many nations. It has been estimated that up to 200 million people have died from this disease.
Morphology
Y. pestis is a Gram-negative coccobacillus that measures 1.5 3 0.7 µm in size, with rounded ends and convex sides. The bacilli are arranged in single, in pairs, or in short chains. Pleomorphism is very common.
Giemsa or methylene blue stained smears of clinical specimens show characteristic bipolar staining (safety pin appearance) with both ends densely stained and a clear central area of the bacteria. Y. pestis is a nonmotile, nonsporing, and non-acid fast but capsulated bacterium.

Yersinia pestis
Culture
Y. pestis is aerobic and facultatively anaerobic. It grows at a temperature range of 2-45oC with an optimum temperature of 27oC. Y. pestis can grow on a variety of media including Mueller-Hinton agar, nutrient agar, blood agar, and MacConkey agar. On nutrient agar, Y. pestis produces small, delicate, and transparent colonies becoming opaque on prolonged incubation.
Blood agar containing sodium azide is a selective medium for Y. pestis.
Biochemical reactions
- Y. pestis is catalase positive, aesculin positive, and MR positive.
- It is coagulase positive. It ferments glucose, maltose, and mannitol with production of acid but no gas. Lactose, sucrose, or rhamnose are not fermented.
- It is oxidase negative, urease negative, and citrate negative.
- It does not reduce nitrate and does not liquefy gelatin. Indole is not produced.
Y. pestis is sensitive to heat, sunlight, drying, and chemical disinfectants. The bacilli are killed at a temperature of 55oC in 30 minutes. They are also killed rapidly by disinfectants, such as 0.5% phenol in 15 minutes.
Pathogenesis and Immunity
Y. pestis is a highly virulent bacterium, which causes plague with a high mortality rate.
Virulence factors
- Plague toxin
- F1 envelope antigen
- V and W antigens
- Type III secretion systems:
Pathogenesis of plague
Plague in humans can occur either by the bite of a vector, by close contact with infected tissue or body fluids, or by direct inhalation of the bacterium.
Bubonic plague: It is a zoonotic disease transmitted by rat flea Xenopsylla cheopis from animals to humans. Y. pestis is a natural parasite of rodents; infection is transmitted and maintained among them by rat fleas.
The bubonic plague is characterized by the pathognomonic 'bubo'. The disease occurs following the bite of rat flea, depositing thousands of bacilli. The bacilli invade the nearby lymphoid tissue producing the characteristic - an inflamed, necrotic, and hemorrhagic lymph node known as 'bubo'as demonstrated in bubonic plague


Pneumonic plague: It is transmitted from humans to humans. It occurs following direct inhalation of the bacilli by droplet infection due to close contact with infected hosts
Septicemic plague: It is usually the terminal stage of the bubonic or pneumonic plague
Epidemiology
Plague is worldwide in distribution with most of the human cases reported from developing countries. India is one of the few countries that have been worst hit by the pandemics of plague. Plague first appeared in Bombay in 1896 and spread all over the country, causing more than 10 million deaths by 1918. Thereafter, it gradually receded, though occasional cases continued to occur in endemic foci till 1967.
Y. pestis inhabit infected lymph nodes-most commonly inguinal lymph nodes in bubonic plague, lower respiratory tract in pneumonic plague, and the blood circulation in septicemic plague./p>
Laboratory Diagnosis
Specimens may include bubo aspirates (in bubonic plague), sputum (in pneumonic plague), and blood and cerebrospinal fluid (CSF) (in septicemic plague).
Microscopy:
Culture
Y. pestis is slow growing, but it does not require any special growth media.
Serological tests usually supplement diagnosis of plague. Enzyme-linked immunosorbent assay (ELISA) and indirect hemagglutination (IHA) tests are employed to detect specific antibodies in acute and convalescent sera.
Treatment
Treatment of a suspected case of plague with antibiotics should be started as early as possible, without waiting for laboratory confirmation
Prevention and Control
These include immunoprophylaxis by plague vaccine, chemoprophylaxis by antibiotic therapy, and environmental sanitation.
Yersinia enterocolitica
Y. enterocolitica is a well-recognized enteric bacterium that causes distinctive clinical manifestations, ranging from asymptomatic infections to life-threatening sepsis, especially in children. This bacillus resembles Y. pseudotuberculosis in being motile at 22oC, but differs from it in fermenting sucrose and cellobiose and decarboxylating ornithine. The bacteria require iron to survive; hence Yersinia sepsis has been reported in children following accidental iron overdose. They grow well on commonly used basic enteric media. On MacConkey agar, they produce pinpoint colorless colonies after 24 hours of incubation.
Humans acquire infection by ingestion of food or water contaminated with the bacteria. On ingestion, the bacteria adhere to the mucosa of terminal ileum, penetrate, and multiply in Peyer patches. The bacteria induce an inflammatory infiltrate in the lamina propria. The outer membrane protein is an important virulence factor that mediates adherence and invasion of the organism.
The bacteria may then spread to the mesenteric lymph nodes and may cause bacteremia, or form abscesses and pain in the right lower quadrant that simulate appendicitis. The incubation period is short, varies from 4 to 6 days. The condition manifests as watery, mucoid diarrhea in majority of patients; fever, colicky abdominal pain, bloody stools; and leukocytes in the stool. Diarrhea usually lasts from 1 day to 3 weeks. Most cases are self-limited.
Yersinia pseudotuberculosis
Y. pseudotuberculosis is the least common of the three main Yersinia species to cause human infections.
Y. pseudotuberculosis is a small, ovoid, and bipolar stained Gram-negative bacillus. It is nonsporing, noncapsulated, and slightly acid fast. It is motile at 22oC but not at 37oC.
Y. pseudotuberculosis primarily causes gastroenteritis. The incubation period varies from 5 to 10 days. Gastroenteritis is characterized by a self-limited mesenteric lymphadenitis simulating acute appendicitis. Fever, abdominal pain (often right lower quadrant location), and rash are a major triad of Y. pseudotuberculosis infection. Diarrhea is not common. Erythema nodosum and reactive arthritis are the noted late complications of the infection.
The pathogen also causes Izumi fever and Far East scarlatinoid fever. Y. pseudotuberculosis is primarily a zoonotic infection. The animal reservoirs include many mammalian and avian hosts, such as horses, cattle, dogs, deer, cats, rabbits, rodents, and birds (e.g., geese, turkey, ducks, canaries, cockatoos). Butchers working in abattoirs slaughtering swine are at an increased risk to Y. pseudotuberculosis infection.
Antibiotic therapy is indicated only for younger patients with critical illness, and in the immunocompromised patients. Tetracycline, aminopenicillins, and aminoglycosides are the antibiotics frequently used for treatment of the condition.
Vibrio, Aeromonas, and Plesiomonas
Vibrio species are oxidase-positive, Gram-negative curved bacilli that are motile by presence of polar flagellum. They are asporogenous and noncapsulated. Vibrios are natural inhabitants of sea water but are also found in fresh water worldwide.
Vibrio cholerae
V. cholerae is the most important species that causes cholera, the most feared epidemic diarrheal disease.
V. cholerae are Gram-negative bacilli with rounded or slightly pointed ends. They measure 1-3 µm in length and 0.5-0.8 µm in diameter.
The bacteria are typically comma shaped. S-shaped or spiral forms may be seen due to two or more cells lying end to end. They may be pleomorphic in old cultures. In a stained film of mucous flakes from a case of cholera, the vibrios are typically arranged in parallel rows, described by Koch as the "fish in a stream" appearance. They are motile by the presence of a single polar flagellum. They show typical darting type motility and appear as a "swarm of gnats" when examined under the microscope. The bacterium is nonsporing, noncapsulated, and nonacid fast.

Culture
V. cholerae grows well on a wide variety of media including nonselective media. V. cholerae is strongly aerobic and grows best under aerobic conditions, whereas growth is scanty and slow under anaerobic conditions. It grows better in an alkaline medium, the range of pH being 7.4-9.6 (optimum 8.2). Sodium chloride (0.5-1%) is required for optimal growth, though high concentrations (5% and above) are inhibitory for growth of the bacteria.
Biochemical reactions
It is catalase positive and oxidase positive.
V. cholerae ferments sugars with production of acid only (no
gas). It ferments glucose, sucrose, maltose, mannitol, and
mannose. It is a late lactose fermenter taking several days incubation to ferment lactose.
It does not ferment arabinose, inositol, and dulcitol.
It forms indole and reduces nitrates to nitrites.
V. cholerae shows positive cholera red reaction by producing
a reddish pink color in the peptone water due to formation
of nitroso indole.
It is methyl red positive and urease test negative.
It liquefies gelatin and decarboxylates lysine and ornithine,
but not arginine.
V. cholerae is most susceptible to heat, drying, acids, and common disinfectants. V. cholerae are killed by heating at 56oC for 30 minutes, killed in a few minutes in gastric juice of normal acidity.
Pathogenesis and Immunity
Cholera is a toxin-mediated disease. Cholera toxin (CTx) produced by V. cholerae is the key virulence factor of the bacteria.
Other virulence factors include:
- Toxin coregulated pilus: The pili help in adherence of V. cholerae to mucosal cells of the intestines.
- Accessory colonization: These also help in adhesion of bacteria to the intestinal mucosa.
- Hemagglutination-protease (mucinase): This enzyme, formerly known as cholera lectin, is both agglutinin- and zincdependent protease.
- Neuraminidase: The enzyme destroys neuraminic acid, thereby increasing toxin receptors for the V. cholerae.
- Siderophores: It is responsible for sequestration of iron.
Pathogenesis and Immunity
V. cholerae usually enters the body orally through contaminated water and food
Vibrios, once adhered to the intestinal wall, produce cholera toxin. The toxin activates cAMP, which inhibits the absorption of sodium transport and activates the excretory chloride transport in the intestinal epithelial cells.
V. cholerae O139 strain shows a similar pathogenic mechanism to that of V. cholerae O1 except that it produces a unique O139 LPS and an immunologically related O antigen capsule. These two virulence factors enhance virulence of this organism.
Immunity in cholera may be produced against the cholera toxin or against the bacteria. Natural infections in cholera induce some degree of immunity for a short duration of 6–12 months. Reinfection occurs in the same person after this period.
Cholera
The incubation period is short and varies from 2 to 3 days after ingestion of the bacteria. The condition shows an abrupt onset of watery diarrhea and vomiting. Profuse watery diarrhea is the most important manifestation of cholera. The volume of diarrheic stool excreted in cholera is much more than that of diarrhea caused by any other infectious pathogen. In a severe condition, patients may excrete as high as 250 mL of stool per kg body weight in a day.
Severe abdominal cramp, possibly caused by distension of the small intestine due to excretion of larger volumes of intestinal fluid, is also seen in these patients. Vomiting is another important manifestation of cholera and occurs in early stage of the disease. This is caused by decreased gastric and intestinal motility.
Dehydration in cholera characteristically develops very fast, within hours after the onset of symptoms. This rapid development of dehydration is not seen with diarrheal diseases caused by any other enteropathogen. In untreated patients, case fatality rate has been estimated to vary from 25% to 50%. In patients treated well with replacement of lost fluid and electrolytes, the case fatality is usually less than 1%.
Epidemiology
Cholera continues to be a major health problem in many parts of the world including Indian subcontinent and sub- Sahara in Africa. The condition is rare in the developed and industrious nations for the last many decades.
Habitat: V. cholerae is a salt water bacterium. Marine ecosystem in association with plankton is the primary habitat of the bacteria. The bacteria can multiply freely in the water
Diagnosis
Fresh stool specimen collected before administration of antibiotics is the specimen of choice. This can be followed with microscopy or culture.
Serotyping: using specific V. cholerae O1 antisera. In this test, the colonies are picked up with a straight wire and mixed with a drop of antisera on the slide. Agglutination of the bacteria shows that the test is positive for V. cholerae O1.
Treatment
Treatment of cholera includes (a) replacement of fluid and electrolytes and (b) antibiotic therapy.
Prevention
The preventive measures against cholera include general preventive measures and cholera vaccination.
Vibrios that require a higher concentration of sodium chloride are known as halophilic vibrios. They are natural inhabitants of sea water and marine life. V. parahaemolyticus,Vibrio alginolyticus, and V. vulnificus are three important halophilic vibrios species known to cause infection in humans.
V. parahaemolyticus is now recognized as an important cause of seafood-associated gastroenteritis throughout the world.
V. alginolyticus is widely distributed in sea water and seafood. V. alginolyticus is associated with infections of superficial wounds exposed to contaminated sea water.
V. vulnificus is a more virulent bacterium than V. parahaemolyticus. Presence of capsule and production of hydrolytic enzymes, such as cytolysins, proteases, and collagenases are responsible for virulence of the bacteria.
Aeromonas
The members of the genus Aeromonas are Gram-negative facultative anaerobic bacilli that morphologically resemble other members of the family Vibrionaceae. They are motile bacilli with the presence of polar flagella. Few strains are nonmotile. They are catalase positive, oxidase positive, and nitrate positive. They ferment sugars with production of both acid and gas.
Aeromonas spp. in humans cause gastroenteritis and wound infections. They are susceptible to chloramphenicol, gentamicin, and trimethoprim-sulfamethoxazole. They are resistant to penicillins, most cephalosporins, and erythromycin.
Plesiomonas
Plesiomonas shigelloides is the only species described in the genus Plesiomonas. It is serologically related to Shigella sonnei and hence shows agglutination with S. sonnei antiserum. But it differs from Shigella by being oxidase positive and motile by the presence of polar flagella. The organisms are ubiquitous in fresh water and brackish water. The bacteria are frequently isolated from dogs, cats, goats, sheep, and other animals, such as frogs, snakes, turtles, and lizards. Humans acquire infection by ingestion of contaminated seafood or contact with amphibians or reptiles.
P. shigelloides in humans causes gastroenteritis. P. shigelloides is resistant to ampicillin, erythromycin, and carbenicillin but is susceptible to trimethoprim-sulfamethoxazole, chloramphenicol, cephalosporins, imipenem, and fluoroquinolones.
Campylobacter and Helicobacter
The family Campylobacteriaceae consists of two genera of medical importance: Campylobacter and Helicobacter. The genera belonging to this family are Gram-negative, spiral bacilli. They are microaerophilic and grow only in the presence of a reduced oxygen concentration. They lack the capacity to oxidize or ferment sugars.
Campylobacter
Campylobacter infections are one of the most common bacterial infections in humans. They cause both diarrheal and other systemic diseases. The generic name Campylobacter is derived from the Greek word Kampylos meaning curved rod. The genus Campylobacter resembles the genus Vibrio in being motile by means of polar flagella and in being curved Gram-negative bacilli and oxidase positive. They, however, differ from vibrios (a) in being microaerophilic, (b) not fermenting carbohydrates and (c) having a lower guanosine and cytosine content of DNA.
Morphology
Campylobacter spp. shows following morphological features: Campylobacter are small, comma-shaped, Gram-negative rods. They vary in width from 0.2 to 0.5 µm. They show a rapid darting motility in cork screw fashion by means of a single polar flagellum at one or both poles (monotrichous/amphitrichous). They are nonsporing bacteria.

Campylobacter jejuni
Culture
Campylobacter are microaerophilic, requiring an atmosphere with decreased oxygen concentration (5%) and increased carbon dioxide concentration (5-10%) for their growth. Most species including C. jejuni, Campylobacter coli, Campylobacter lari, and Campylobacter hyointestinalis grow well at 42oC, hence are called thermophilic bacilli.
Biochemical reactions
Campylobacter are relatively biochemically inert. They do not produce indole. They are oxidase positive, catalase positive (C. jejuni subsp. doyle is an exception), and nitrate positive. C. jejuni is the only species that hydrolyzes sodium hippurate.
Campylobacter spp. survive at 4°C in Cary-Blair transport medium for many weeks. Campylobacter spp. are sensitive to hydrochloric acid in the stomach, and so conditions that decrease or neutralize gastric acid secretion reduce the amount of inoculum needed to cause disease.
Pathogenesis and Immunity
C. jejuni possesses many virulence factors, such as enterotoxins, lipopolysaccharide (LPS), adhesins, and cytotoxic enzymes. However, specific role of these virulence factors in the pathogenesis of disease is not well-known.
Three mechanisms have been postulated in the pathogenesis of intestinal disease caused by C. jejuni:
- Adherence and production of heat-labile enterotoxins.
- Invasion and proliferation of bacteria within the intestinal epithelium.
- Invasion of intestinal mucosa and proliferation.
C. fetus is more frequently associated with systemic infections, such as bacteremia. A single protein, namely, S protein, found in C. fetus is the major virulence factor. It inhibits C3b binding responsible for both the serum and phagocytic resistance of the bacteria. Hence, it makes the bacteria resistant to the bactericidal effects of serum.
Campylobacter spp. infections in humans can be broadly classified into two major groups: (a) enteric infections and (b) extraintestinal infections. Campylobacter spp. infections in humans can be broadly classified into two major groups: (a) enteric infections and (b) extraintestinal infections.
C. jejuni is the most important species associated with human enteric infections. The clinical manifestations of enteric infections caused by all the Campylobacter species including C. jejuni are similar. Watery diarrhea is the main manifestation and occurs in approximately 10% of children. The condition is also associated with abdominal pain, malaise, myalgia, headache, and vomiting. The condition is self-limiting.
Extraintestinal infections include Bacteremia and Perinatal infection.
Guillain-Barre syndrome is an autoimmune disease believed to be due to molecular mimicry of terminal tetrasaccharide of LPS of C. jejuni and glycosphingolipid present on the surface of peripheral nerve. This is a disease of peripheral nerves and is characterized by ascending paralysis. A rare serotype of C. jejuni called Penner (LPS type O: 19) is associated with this condition.
Epidemiology
Campylobacter infections are extremely common worldwide. The average incidence of Campylobacter bacteremia in developed countries is estimated to be 1.5/1000 patients with enteritis. In developing countries, although exact figures are not available, C. jejuni is frequently isolated from stool of healthy children
Campylobacter infections are zoonotic. Infected animals are the main reservoir of the infection. The animal reservoirs are the dogs, cats, and other pets that carry the organism in their gastrointestinal tract.
Transmission occurs most commonly from infected animals and their food products. Most human infections occur by ingestion of contaminated and improperly cooked poultry meat products. Infected chickens may account for 50–70% of the infection. The infection also occurs by drinking contaminated raw milk or unpasteurized milk. It is worth noting that infections may be transmitted from person to person through sexual contact.
Diagnosis
Diarrheic fresh stool is the specimen of choice for enteric infections. Rectal swab may also be used. Other specimens include blood or body fluids. These specimen can be evaluated by microscopy, culture, histology where appropriate. ELISA is available for demonstration of specific antibodies in the serum, and a high titer of antibodies is usually seen after the symptoms are resolved. Serology may not be useful for routine diagnosis, but is useful for epidemiological studies.
Treatment
Most C. jejuni infections are mild and self-limited. Therefore, they do not require antibiotic therapy. Supportive treatment is adequate. Treatment with antibiotics is recommended only for persons with fever, bloody diarrhea, or with symptoms persisting for more than 7 days, and for immunocompromised patients.
Prevention and Control
Thorough cooking of all poultry products and strict personal hygiene.
Helicobacter
Helicobacter are Campylobacter-like bacteria with a spiral or helical morphology. They are motile by means of sheathed flagella. Helicobacter spp. inhabit stomach of humans and many other mammals.
Helicobacter pylori
H. pylori is associated with gastritis, peptic ulcer, gastric adenocarcinoma and gastric mucosa-associated lymphoid type (MALT), and B-cell lymphoma.
Morphology
H. pylori is a curved, spiral, or S-shaped Gram-negative bacillus measuring 3 µm in length and 0.5–0.9 µm in breadth. The organism is highly motile and shows cork screw motility due to presence of a unipolar tuft of lophotrichous flagella. It is nonsporing.

Culture
H. pylori is microaerophilic and grows in the presence of decreased oxygen concentration (5%) and increased carbon dioxide concentration (10%) in a temperature range between 30 and 37oC. The bacteria do not grow anaerobically. The bacteria grows well on freshly prepared chocolate agar and Skirrow's campylobacter media. H. pylori produces circular, convex, and translucent colonies on these media, after incubation of 3-5 days.
Biochemical reactions
H. pylori produces the enzyme urease, which is almost 100
times more active than that produced by Proteus vulgaris.
Urease production is the most important feature of H. pylori.
H. pylori is catalase and oxidase positive.
These are biochemically inactive and do not ferment or oxidize
sugars, although they can metabolize amino acids by
fermentative pathways.
Pathogenesis and Immunity
Virulence factors include
- Urease
- Flagella
- Adhesins
- Enzymes
- Heat shock protein (Hsp-B)
- Acid inhibitory protein
- Cytotoxin
Pathogenesis of H. pylori infection
H. pylori blocks the production of acid by its acid-inhibitory protein and also neutralizes the gastric acidity by production of ammonia by splitting urea by the enzyme urease. Through their active cork-screw motility pass through gastric mucosa and adhere to epithelial cells. The adhesion is mediated by many adhesin proteins
After adhesion, damage to the epithelial cells is caused by multiple factors, such as mucinases, phospholipases, and vacuolating aflatoxin and by products of urease. Finally, Helicobacter infection causes atrophic and even metaplastic changes in the stomach.
Antibodies and also cellular immunity do not appear to confer any protection against the disease.
H. pylori is now accepted to be the infective pathogen that causes most of the gastric and duodenal ulcers. Treatment of H. pylori infection by specific antibiotics, and thereby the elimination of organism from the stomach, results in healing of these ulcers and in marked reduction in the recurrence of ulcers.
H. pylori infection causes chronic atrophic gastritis during later stage of the illness.
Epidemiology
H. pylori is ubiquitous, found worldwide. H. pylori infection occurs more frequently in developing countries than in the developed countries. Humans are the primary reservoirs of infection. The prevalence rate of H. pylori infection may differ based on geographical area and race. The prevalence rate is approximately 60% in Hispanic persons, 54% in African American persons, and 20% in White persons. Poor hygiene, overcrowding, and poverty facilitate the spread.
Diagnosis
Specimens include stool samples and gastric biopsy specimen. These specimens undergo microscopy, culture or fecal antigen test. ELISA tests identify presence of antibodies but is not conclusive because antibodies last in blood long after the bacteria has been eradicated.
Treatment
H. pylori is sensitive to several antibiotics and to bismuth salts. Use of a single antibiotic or an antibiotic contained with bismuth is not effective. More success has been achieved for treatment of gastric or peptic ulcer by using a combination of bismuth, a proton pump inhibitor (e.g., omeprazole), and one or more antibiotics (ampicillin, metronidazole, clarithromycin, tetracycline). The combination of three types of drug is known as triple therapy and is usually given for either 10 or 14 days.
Pseudomonas, Burkholderia and Moraxella
Pseudomonas is a genus of Gram-negative, Gammaproteobacteria, belonging to the family Pseudomonadaceae and containing 191 validly described species. The members of the genus demonstrate a great deal of metabolic diversity and consequently are able to colonize a wide range of niches. Because of their widespread occurrence in water and plant seeds such as dicots, the pseudomonads were observed early in the history of microbiology. The generic name Pseudomonas created for these organisms was defined in rather vague terms by Walter Migula in 1894 and 1900 as a genus of Gram-negative, rod-shaped, and polar-flagellated bacteria.
Pseudomonas aeruginosa
P. aeruginosa is the most important species associated with human infection. It is a most common human saprophyte, but it rarely causes disease in healthy individuals. P. aeruginosa causes most of human infections in immunocompromised people.
Morphology
P. aeruginosa is a straight or slightly curved, Gram-negative
bacillus measuring 0.5-1.0 X 1.5-5.0 µm in size arranged
singly, in pairs, or in short chains. It is motile by the presence of a polar flagellum. Occasionally, strains may possess two or three polar flagella.
Pseudomonas spp. is noncapsulated. Although the bacteria are
noncapsulated, many strains appear mucoid by production
of an abundant of extracellular polysaccharide

Culture
Pseudomonas spp. are strictly aerobic bacteria. P. aeruginosa grows over a wide range of temperatures (5-32oC), the optimum temperature being 37oC. P. aeruginosa grows on commonly used routine media including nutrient agar, blood agar, MacConkey agar, and deoxycholate citrate agar (DCA).
Biochemical Reactions
Pseudomonas spp. are oxidase positive. Oxidase test is an important test
for identification of P. aeruginosa. All the strains are oxidase
positive within 30 seconds of performing the test.
They are incapable of fermentation. They utilize sugars
by an oxidase metabolism, with oxygen as the terminal
electron acceptor.
They do not utilize lactose and maltose.
They reduce nitrates to nitrite, which is further broken down
to gaseous nitrogens.
They are catalase positive and arginine dihydrolase positive.
They are indole, MR, VP, and H2S negative.
P. aeruginosa is heat-labile bacterium, readily killed at 55oC in 1 hour. It is also highly susceptible to acid, silver salts, 2% alkaline, glutaraldehyde, and disinfectants (such as Dettol and cetrimide).
Pathogenesis and Immunity
Virulence factors
- Exotoxin A: Acts by prevention of synthesis of proteins in eukaryotic cell.
- Exoenzymes S and T: These toxins show adenosine diphosphate ribosyl transferase activity, inhibit protein synthesis, and cause immunosuppression.
- Elastase: Destroys elastin present in elastin-containing tissues (skin, lung tissue, blood vessels, etc.).
- Alkaline protease: Causes tissue destruction, inactivation of interferon.
- Phospholipase C: Causes tissue destruction by breaking down lipids and lecithin.
- Rhamnolipid: Breaks down lecithin-containing tissues.
- Pili: Adhesion of the bacteria to the epithelial cells.
- Capsule: Inhibits antibiotics killing of the bacteria.
- Lipopolysaccharide: Endotoxic activity, sepsis.
- Pyocyanin: Causes tissue damage, inflammation.
- Alginate-like exopolysaccharide: Responsible for mucoid phenotype.
Clinical Syndromes
P. aeruginosa are opportunistic pathogens as well as true pathogens. P. aeruginosa as true pathogen cause infections of the respiratory tract in patients with underlying disease of the respiratory tract. They also cause infection of urinary tract in patients with catheterization. P. aeruginosa as opportunistic pathogens causes most of human infections in immunocompromised people.
The pathogen causes several diverse conditions such as:
- Respiratory tract infections: P. aeruginosa infection of the lower respiratory tract occurs almost exclusively in patients with malignancies and immunodeficiencies.
- Skin infections: P. aeruginosa can cause a variety of skin infections, such as infections of burn wound, chronic paronychia, infected toe web, pseudomonal folliculitis, and pseudomonal cellulitis.
- Urinary tract infections: P. aeruginosa causes urinary tract infections in persons with indwelling urinary catheters and in persons undergoing instrumentation and surgery of urinary tract.
- Ear infections: P. aeruginosa is one of the common agents causing external otitis in patients with history of swimming.
- Eye infections: P. aeruginosa causes pseudomonal endophthalmitis. The condition may occur following trauma, intraocular surgery, or posterior perforation of corneal ulcer.
- Endocarditis: Pseudomonal infectious endocarditis is caused by involvement of both normal and abnormal valves (tricuspid, aortic, and mitral valve) on both sides of the heart. This condition leads to destruction of heart valves and subsequent heart failure.
- Nosocomial infections: Most infections caused by P. aeruginosa are opportunistic infections seen in immunocompromised host.
Epidemiology
P. aeruginosa are the opportunistic pathogens, causing infection, distributed worldwide. The bacteria are specially found in the hospital environment.
Diagnosis
Laboratory diagnosis of pseudomonal infection is based on isolation of P. aeruginosa from feces or other clinical specimens containing mixed microbial flora by culture on selective medium
Treatment
P. aeruginosa shows a considerable degree of resistance to many of the commonly used antibiotics. Pseudomonas are susceptible to cefotaxime, ceftazidime, gentamicin, tobramycin, carbenicillin, azlocillin, and ticarcillin. Ciprofloxacin is most frequently used antibiotic.
Prevention and Control
Prevention of cross-infection of patients by attending medical and paramedical personnel.
Prevention of contamination of equipments, such as dialysis machine and respiratory instruments and restricting the use of broad-spectrum antibiotics.
Other Pseudomonas Species
P. stutzeri, P. putida, Pseudomonas maltophilia, and P. fluorescence are also associated with opportunistic infections in humans. P. stutzeri is associated with occasional urinary tract infection.
Burkholderia
The genus Burkholderia includes four species, which were formerly classified as Pseudomonas species. These include Burkholderia cepacia, Burkholderia pseudomallei, Burkholderia gladioli, and B. mallei.
Burkholderia cepacia
It is the causative agent for bacterial rots in onions. The bacteria were first reported as the causative agent of endocarditis in 1950s. Subsequently, the bacteria are being increasingly reported to be associated with urinary tract infections, catheter-associated bacteremias, and wound infections in humans. B. cepacia is susceptible to trimethoprim-sulfamethoxazole, chloramphenicol, and ceftazidime.
Burkholderia mallei
The bacterium is known to cause glanders, which is a serious disease of equine animals, but capable of transmission to other animals (goats, dogs, and cats) and humans
Glanders in animals may be diagnosed by a skin test known as Mallein test. The skin test is similar to the tuberculin test demonstrating a delayed hypersensitivity reaction to protein of B. mallei.
Burkholderia pseudomallei
B. pseudomallei is also known as Whitmore's bacillus. It is the causative agent of melioidosis.
Moraxella
Genus Moraxella consists of at least seven species, which can cause infections in humans. These are Moraxella catarrhalis, Moraxella lacunata, Moraxella nonliquefaciens, Moraxella osloensis, Moraxella phenylpyruvica, and Moraxella atlanta.
Moraxella are Gram-negative cocci or short rods recognized on the basis of nucleic acid analysis. They are arranged mainly in pairs and may be confused with those of gonococci. They are nonmotile, noncapsulated, and nonflagellated bacteria. They are oxidase and catalase positive. They do not produce acid from carbohydrates. They are obligate aerobes and grow well at 32-36oC. They produce small colonies on blood agar after 24 hours of incubation but show poor or no growth on MacConkey agar.
They are resistant to penicillins due to production of beta-lactamases; and susceptible to other antibiotics, such as trimethoprim- sulfamethoxazole, erythromycin, tetracyclines, and cephalosporins.
Haemophilus, Pasteurella, and Actinobacillus
Members of these three genera cause several diseases in humans. They require complex media for their growth and isolation.
Haemophilus
The members of the genus Haemophilus are small, sometimes pleomorphic, Gram-negative, nonmotile, and nonsporing organisms. They require one or both the accessory growth factors, namely, X and V present in the blood. Hence, the genus derived its name from its essential growth requirement of certain factors, such as X and V present in the blood (haemophilus: haem, blood; philus, loving).
Haemophilus influenzae and Haemophilus ducreyi are two major species associated with disease in humans.
Haemophilus influenzae
It is the most common species associated with human disease. It is an important cause of meningitis in children and also of respiratory tract infection in children as well as in adults
Morphology
H. influenzae is a small, pleomorphic, Gram-negative bacillus. It measures 1 X 0.3 µm. In fresh cultures, the bacteria are usually coccobacilli, while in older cultures, long filamentous forms are seen. The bacteria are nonmotile, nonsporing, and nonacid fast.

Culture
It is facultative anaerobe, grows better in anaerobic condition. The optimal temperature is 35-37oC. They do not grow below 22oC. Presence of 5-10% CO2 enhances the growth of the bacteria.
Growth factors: H. influenzae requires two erythrocytic growth factors, X factor and V factor. These factors are released following lysis of blood cells, thereby allowing growth of fastidious H. inf luenzae on the chocolate agar.
Biochemical reactions: H. influenzae is catalase and oxidase positive. It ferments glucose and galactose, but does not ferment lactose, sucrose, and mannitol. It reduces nitrates to nitrites. H. influenzae is a delicate bacillus. It is readily killed within 30 minutes by moist heat at 55oC. It dies within a few days at 4oC as well as in culture plates and dies in less than 2 days in dried clinical secretions. Bacteria are sensitive to commonly used disinfectants and also to desiccation.
Pathogenesis and Immunity
Virulence factors
- Capsular polysaccharide: Resists phagocytosis.
- Lipopolysaccharide: causes meningococcal inflammation.
- IgA1 protease: Breaks down IgA.
- Pili: Helps in adherence to epithelial cells.
Clinical Syndromes
Infections caused by encapsulated H. influenzae
Meningitis: Meningitis is the most serious manifestation of Hib infection. It occurs primarily in children of 2 months to 2 years of age.
Epiglottitis: Epiglottitis is the second most common infection of H. influenzae and is a life-threatening emergency. This condition is seen in children of 3-18 months of age after Hib vaccine era.
Cellulitis: H. influenzae causing cellulitis is typically seen in children.
Septic arthritis: Septic arthritis in children is characterized by involvement of single large joint, such as knee, ankle, hip, or elbow.
Pneumonia: Pneumonia typically occurs in infants and is clinically indistinguishable from other bacterial pneumonias.
Infections caused by nonencapsulated strains
These strains cause otitis media, bronchitis, pneumonia, and conjunctivitis. Nonencapsulated H. influenzae along with Streptococcus pneumoniae is the most common cause of otitis media.
Epidemiology
Hib was a leading cause of infections among children worldwide before Hib vaccines became available. After the availability of the Hib vaccine, the frequency of invasive Hib disease has reduced remarkably even in the developing countries.
Diagnosis
CSF and blood are the specimens of choice for the diagnosis of meningitis. Blood is a frequently used specimen for culture for diagnosis of cellulitis, epiglottitis, arthritis, or pneumonia caused by Hib. Sepcimens are analysed through microscopy and/or culture to detect the bacteria.
Treatment
H. influenzae is susceptible to sulfonamides, chloramphenicol, ciprofloxacin, ampicillin, cefotaxime, and ceftazidime. Cefotaxime and ceftriaxone are the initial drugs of choice of treatment of Hib meningitis.
Prevention and Control
The Hib conjugate vaccine, now routinely given to infants and children, is highly effective. The vaccine has dramatically reduced the prevalence of invasive Hib disease. Chemoprophylaxis by rifampin is used to reduce the colonization of Hib disease in children with high risk.
Other Haemophilus Species
Haemophilus ducreyi: an important causative agent of sexually transmitted disease called soft sore or chancroid in Asia and Africa.
Haemophilus aphrophilus: is present as a commensal in the mouth and in the throat.
Haemophilus parainfluenzae: H. parainfluenzae is an opportunistic pathogen in the upper respiratory tract. Occasionally, the bacteria may cause endocarditis, conjunctivitis, and bronchopulmonary infection.
Haemophilus aegyptius: was earlier known as Koch-Weeks bacillus. This was observed by Koch in 1883 in a case of acute conjunctivitis and subsequently was first cultured by Weeks in 1887. The organism causes highly contagious form of acute conjunctivitis
Haemophilus haemolyticus: Present as a commensal in the upper respiratory tract. It is a nonpathogen and does not cause any human disease.
Pasteurella
Pasteurella are nonmotile Gram-negative coccobacilli and are aerobes and facultative anaerobes. They show a bipolar appearance in stained smears. They grow on blood agar and chocolate agar, but show variable growth on the MacConkey agar. They are commonly found as commensals in the oropharynx of healthy animals and cause septicemia in a variety of animals and birds. They are found rarely in the human oropharynx.
The genus Pasteurella consists of more than 17 species. Pasteurella multocida is the most common species causing infection in humans. Other species, which rarely cause human infections, include Pasteurella canis, Pasteurella dagmatis, Pasteurella pneumotropica, Pasteurella aerogenes, Pasteurella haemolytica, Pasteurella caballi, and Pasteurella bettyae.
Pasteurella multocida
P. multocida is a nonmotile Gram-negative bacillus. The organism generally resembles Yersinia, but differs from it in being oxidase positive and producing indole.
P. multocida is present in the upper respiratory tract of dogs, cats, rats, cattle, and sheep. Human infection is rare but may occur following animal bites or trauma. After a bite or scratch by cats or dogs, a localized cellulitis and adenitis occurs at the site of bite.
Penicillin is the antibiotic of choice. Tetracycline, cephalosporins, or fluoroquinolones are other antibiotics equally effective against the bacteria.
Actinobacillus
Actinobacillus are small, nonmotile, and facultative anaerobic Gram-negative bacilli. The bacteria grow slowly on culture media requiring 2-3 days of incubation. The genus Actinobacillus consists of at least six species, and Actinobacillus actinomycetemcomitans is the most important human pathogen.
Actinobacillus actinomycetemcomitans
The bacteria in humans constitute the normal flora of the oral cavity, particularly in the gingival and supragingival cervices.
A. actinomycetemcomitans grows slowly on chocolate and blood agar producing demonstrable colonies after 2-3 days of incubation. On blood agar, the colonies are smooth, translucent, and nonhemolytic with irregular edges.
A. actinomycetemcomitans can cause subacute bacterial endocarditis particularly in patients with preexisting valvular heart diseases and oral diseases, such as oral abscess, poor oral hygiene, periodontitis, etc.
Bordetella and Francisella
The genus Bordetella includes the bacteria that are extremely small, strictly aerobic, nonfermentative, and Gram-negative coccobacilli. These are obligate respiratory tract pathogens of warm-blooded animals including birds. The genus Francisella includes the bacteria that are strictly aerobic and fastidious, hence cannot be cultured on common laboratory media.
Bordetella
The genus Bordetella consists of seven recognized species; of which, three are responsible for human diseases.
Bordetella pertussis
Bordetella pertussis is the causative agent of whooping cough, an infectious bacterial illness that affects the respiratory tract.
Morphology
B. pertussis are extremely small ovoid coccobacilli measuring 0.2-0.5 X 1 µm. They are Gram negative, occurring in singles or in pairs, and are nonmotile and nonsporing. Characteristically, they demonstrate pleomorphism in their morphology. In culture smears, the bacilli are arranged in loose clumps with clear spaces in between, giving a thumbprint appearance.
Culture
B. pertussis is a strict aerobe with an optimum temperature for growth 35oC. The bacteria are nutritionally fastidious. They do not grow on common laboratory media. Even on blood agar, the bacteria grow slowly and require 3-6 days to form pinpoint colonies. The bacteria are usually grown on a rich medium supplemented with charcoal, starch, blood, albumin, and growth factors, such as nicotinamide. The latter is absolutely essential for the growth of the bacteria.
Biochemical reactions
B. pertussis is oxidase positive, catalase positive and does not ferment carbohydrates. The bacteria also do not produce indole, do not reduce nitrate, do not split urea, and do not utilize citrate.
B. pertussis is killed by heating at 55oC for 30 minutes. It is also killed by drying and also by standard disinfectants. If left on culture plates, the bacteria die within few days.
Pathogenesis and Immunity
B. pertussis colonizes the cilia of mammalian respiratory epithelium. The organism usually does not invade the tissues. In addition, B. pertussis causes pertussis or whooping cough in two stages. The first stage is characterized by colonization, multiplication of bacteria, and production of localized tissue damage. The second stage of toxemia is characterized by manifestation of systemic toxicity produced by a myriad of toxins.
Virulence factors
B. pertussis produces several virulence factors (Table 39-2). These include (a) filamentous hemagglutinin (FHA), (b) pertussis toxin, (c) invasive adenylate cyclase, (d) lethal toxin, and (e) tracheal cytotoxin.
An attack of whooping cough gives lifelong immunity to a child. Secondary attack is extremely rare. The immunity is conferred by specific serum antibodies against B. pertussis.
Whooping cough
Whooping cough is also known as pertussis. Incubation period varies from 7 to 10 days. The disease typically has three stages (a) catarrhal stage, (b) paroxysmal stage, and (c) convalescent stage.
Catarrhal stage: This is the first stage of whooping cough. This stage resembles that of upper respiratory tract infection with running nose, nasal congestion, sneezing and general malaise.
Paroxysmal stage: This is the second stage of the disease. This stage is characterized by classic whooping cough or paroxysms. Each paroxysm consists of a series of repetitive intense and drawn out bouts of cough followed by an inspiratory whoop. The attack is more frequent at night with an average 15 attacks in a period of 24 hours.
Convalescent stage: This is the third stage of the disease, which may last for weeks or months. It is characterized by a chronic cough that becomes less paroxysmal. This stage is marked by many complications. These include subconjunctival hemorrhage, respiratory distress, secondary bacterial pneumonia, and neurological complications, such as convulsions. These neurological complications may result in permanent sequelae, such as epilepsy, paralysis, blindness, and deafness.
Epidemiology
Whooping cough is endemic worldwide and affects more than 600,000 million people annually. This is an important cause of mortality in children with estimated 51,000,000 cases and 600,000 deaths annually, particularly in the countries where vaccines are not used regularly.
Diagnosis
Specimens: Nasopharyngeal aspirates are the specimen of choice for demonstration of bacteria by microscopy and culture.
Specimens for culture are collected by the following methods: (a) the pernasal swab, (b) cough plate method, and (c) West's postnasal swab.
Prevention and Control
Vaccination of infants and children with pertussis vaccine is very effective. The vaccination is usually given for children below 7 years of age.
Treatment
Erythromycin is the drug of choice. Tetracycline, chloramphenicol, and ampicillin are also effective.
Bordetella parapertussis
B. parapertussis is a less frequent cause of whooping cough. The bacteria are responsible for only about 5% of cases of whooping cough. They relatively cause mild disease.
Bordetella bronchiseptica
B. bronchiseptica is responsible for causing very small proportion (0.1%) of cases of whooping cough. The bacteria grow on nutrient agar and are antigenically related to B. pertussis and Brucella abortus.
Francisella tularensis
F. tularensis causes tularemia, also known as glandular fever, rabbit fever, tick fever, and deerfly fever-an acute, febrile, granulomatous, infectious disease in humans and other mammals.
Morphology
F. tularensis is a small (0.2 X 0.2 to 0.7 µm) and poorly
stained Gram-negative intracellular coccobacillus.
The bacterium is capsulated and nonmotile.
Culture
Like Bordetella, the bacteria are strictly aerobic and fastidious, hence cannot be cultured on common laboratory media. The organism requires enriched media, such as Francis' blood dextrose cystine agar and a longer period of incubation of 3-5 days. F. tularensis produces minute transparent colonies on these media after incubation of 3-5 days.
F. tularensis is killed by heating at 55oC for 30 minutes. It is also killed by drying and by standard disinfectants.
Pathogenesis and Immunity
F. tularensis is one of the most infectious bacteria known because of: (i) its high infectivity, (ii) ease of dissemination, and (iii) ability to cause substantial illness and death.
Capsulated strains of F. tularensis are pathogenic, while noncapsulated strains are nonpathogenic.
F. tularensis is an intracellular parasite. In infected animals, the bacteria are found in large numbers in the reticuloendothelial cells of spleen, liver, etc. These bacteria remain viable for a longer period in macrophages of the reticuloendothelial system
Tularemia
The incubation period varies from 3 to 5 days. The onset of the disease is abrupt and can manifest in one to six well recognized clinical forms including (a) ulceroglandular tularemia, (b) glandular tularemia, (c) occuloglandular tularemia, (d) oropharyngeal tularemia, (e) pneumonic tularemia, and (f) typhoidal (septicemic) tularemia.
Epidemiology
F. tularensis has a worldwide distribution. The infection is found in more than 100 species of animals, birds, amphibians, and arthropod hosts. Rabbits, ticks, and muskrats are the reservoir of infections. Domestic cats are also now increasingly recognized as reservoirs of tularemia. Ticks and deerflies are common vectors. Hard ticks (Amblyomma americanum, Dermacentor andersoni, and Dermacentor variabilis) are also important vectors and reservoirs due to the vertical transmission of their progeny.
The infection is transmitted by (a) ingestion of poorly cooked meats of the infected animals, such as rabbit, (b) ingestion of contaminated water, (c) bite of a tick or deerfly, (d) direct contact with contaminated soil, water, or fomites, and (e) inhalation of water aerosols or dust from soil, grains, or contaminated pelts. Person-to-person transmission is rare.
Diagnosis
F. tularensis is a highly infectious bacterium. Isolation of the bacteria from clinical specimens is not attempted in routine laboratories. Culture plates must be sealed and handled by using a biosafety level (BSL)-2 facility that is essential for handling the culture plates and BSL-3 facility for isolation and identification of F. tularensis isolates.
Specimens: Sputum, pleural fluid, wounds, blood, lymph node biopsy samples, and gastric washings are the specimens culture, but isolation rate is very low.
Treatment
Streptomycin is the antibiotic of choice for treatment of tularemia. Gentamicin is used as an alternative to streptomycin. Fluoroquinolones are now increasingly used in treatment of tularemia.
Prevention and Control
Avoidance of exposure to tick bites and to dead or wild mammals, if possible, prevents the disease. Frequent and thorough hand washing is also useful. A vaccine is available but only confers partial protection.
Brucella
The genus Brucella consists of small, nonmotile, nonsporing, nontoxigenic, nonfermenting aerobic, and Gram-negative coccobacilli. Brucella can grow on a variety of culture media including serum dextrose, blood, and chocolate agar.
The genus Brucella consists of seven species, four of which are human pathogens. These are Brucella abortus, Brucella melitensis, Brucella suis, and Brucella canis.
Morphology
Brucella are small coccobacilli, measuring 0.5-0.7 X 0.6-1.5 µm in size. Bacterial cells are arranged singly, sometimes in pairs, or in short chains. They do not produce spores, flagella, or capsule.
Culture
Brucellae are strict aerobes. Most biovars of B. abortus require 5-10% CO2 for their growth. No growth occurs in aerobic conditions. They grow at a temperature range of 22-40oC (with an optimum temperature of 37oC) and pH range of 6.6-7.4. Brucellae can grow on simple media, but their growth is slow and scanty. Growth is improved by addition of serum, blood, liver extract, and glucose. Brucella organisms grow best on trypticase soy based or other enriched media. Blood agar and trypticase soy agar are the media of choice.
Biochemical Reactions
Brucellae are catalase and oxidase positive (except for B. ovis and B. neotomae, which are oxidase negative). They reduce nitrate to nitrite and have variable urease activity; B. suis becomes urease positive within 30 minutes, while B. abortus becomes positive within 1-2 hours. Some Brucella species produce H2S, while some species do not produce H2S. They do not utilize Citrate and do not produce indole. They do not ordinarily ferment any sugars.
The brucellae are rapidly killed at 60oC in 10 minutes; hence they are killed by pasteurization in the milk. They are also killed by disinfectants, such as 1% phenol in 15 minutes.
Pathogenesis and Immunity
Brucella like other Gram-negative bacterium contains LPS in the outer cell membrane of the cell walls. But, the LPS of Brucella is different both structurally and functionally from that of other Gram-negative bacteria. LPS is the principle virulence factor of Brucella spp. Intracellular location of the bacteria makes them resistant to killing in serum and also by phagocytes.
Brucellosis
Brucellosis is a systemic disease in humans that can involve almost any organ system. They enter through (a) abrasion or cut in the skin, (b) conjunctiva, (c) respiratory tract, and (d) gastrointestinal tract. Shortly after gaining entry to the body, brucellae are rapidly ingested by polymorphonuclear leukocytes, which are attracted to the site of inflammation. But inside the leukocytes, the brucellae are not killed due to the presence of enzyme superoxide dismutase. Brucellae that are not killed by leukocytes spread from the site of infection to the local lymph nodes which drain the site of infection. Inside the lymph glands, the bacteria multiply and are released to the blood stream following rupture of the cells and are phagocytosed by the macrophages.
The incubation period may range from 3 days to several weeks.
Human infections may be of three types, as follows:
(a) Acute brucellosis: Patients usually complain
of nonspecific symptoms, such as anorexia, fatigue, weakness,
malaise, or joint pain.
(b) Chronic brucellosis: This condition develops in incompletely
treated patients. This condition is associated with a lowgrade
nonbacteremic infection.
(c) Localized infection: B. suis is more likely to cause localized
and suppurative infection.
Brucella endocarditis is the most dangerous complication and is responsible for 80% of deaths in brucellosis.
Epidemiology
Brucella infection is worldwide in distribution. The condition is endemic in certain Mediterranean countries. More than 500,000 cases of brucellosis are reported annually.
Brucella species cause infection in a wide range of hosts but B. melitensis infects goats and sheep; B. abortus, cattle; B. suis, swines; and B. canis, dogs and foxes. Infected animals, such as cattle, goats, sheep, buffalos, and swine are the important reservoirs of infections. Humans acquire infection from animals directly or indirectly. Brucella organism is transmitted to humans by the following ways: (a) ingestion, (b) direct contact, (c) inhalation, and (d) accidental inoculation.
Diagnosis
Clinical diagnosis of brucellosis is very difficult due to protean manifestation of the disease.
Blood is the specimen of choice and is collected for culture and for serological test. Bone marrow and sometimes synovial fluid and pleural fluid are also collected for culture. Specimens such as liver and lymph nodes can also be cultured for isolation of Brucella organisms.
Gram staining is not useful for demonstration of Brucella organisms in clinical specimens due to their small size and intracellular location.
Serological tests are useful for diagnosis of subclinical brucellosis and for cases of acute and chronic brucellosis by demonstration of specific antibodies in patient's serum.
Brucella skin test: Brucella skin test is a delayed type of hypersensitivity reaction to brucella antigen. In this test, brucellin, a protein extract of the bacteria, is used as an antigen and is administered intradermally. The presence of erythema and induration of 6 mm or more within 24 hours is suggestive of positive reaction. This test is positive only in chronic brucellosis but negative in acute brucellosis. Repeated negative skin test excludes brucellosis.
In animals, a culture of milk and urine from infected animals may give positive results. Rapid latex agglutination test and Rose Bengal card test are the rapid diagnostic methods, and are also used for diagnosis of brucellosis in cattle population.
Milk ring test: This is a frequently used serological test for demonstration of antibodies in the milk of an animal. In this test, a concentrated suspension of killed B. abortus or B. melitensis stained with hematoxylin is used as antigen. This test is performed by adding a drop of colored brucella antigen to a sample of whole milk in a test tube. Then it is mixed, and mixed suspension is incubated in water bath at 70oC for 40-50 minutes. In a positive test, if antibodies are present in the milk, the bacilli are agglutinated and raised with the cream to form a blue ring at the top, leaving the milk unstained. In a negative test, the milk remains uniformly blue without formation of any colored ring.
Treatment
Brucellae are sensitive to a number of oral antibiotics and aminoglycosides. The combination of tetracycline and doxycycline is effective against most species of Brucella. Relapse is common on therapy with a single drug. So, the combination of antibiotics is recommended whenever possible.
Prevention and Control
Pasteurization or boiling of milk is most important to prevent transmission of brucellosis in humans, as most of the human infections are acquired by ingestion of contaminated milk and milk products. Also, use of protective clothing and gloves by persons handling or coming into close contact with animals prevents transmission of infection.
Vaccination of animals is effective to control brucellosis in animals. No vaccine is available for humans.
Mycobacterium tuberculosis
The name Mycobacterium is derived from the word 'mould' meaning fungus-like bacterium. Members of the family Mycobacteriaceae consists of nonmotile, non–spore-forming, and aerobic bacilli. They are slightly curved rods, sometimes showing filamentous and branching forms. Most mycobacteria are slow growers, the generation time being 2-24 hours. These bacteria require 3-8 weeks of incubation to produce demonstrable colonies on the solid media.
Mycobacterium leprae was the first species of the genus Mycobacterium to be identified by Hansen in 1874. Subsequently, Mycobacterium tuberculosis was demonstrated as the causative agent of tuberculosis.
Mycobacterium tuberculosis complex is the term used to group four species that can cause tuberculosis
in humans and other mammals.
M. tuberculosis, the human type; Mycobacterium bovis, bovine type;
Mycobacterium africanum, a species intermediate between human and bovine type and causing human tuberculosis mostly in tropical Africa; and
Mycobacterium microti
, another species which is pathogenic for goats and other small animals but does not cause any human infection.
Mycobacterium tuberculosis
Morphology
M. tuberculosis organisms are straight or slightly curved rods
occurring singly, in pairs, or in small clumps. They measure about 3 X 0.3 µm in size; sometimes long filamentous
forms are also seen. M. bovis is usually shorter and
stouter than M. tuberculosis.
They are Gram positive but are difficult to stain. They stain
poorly with Gram staining. They are nonmotile, nonsporing, and noncapsulated.
Ziehl-Neelsen (ZN)-staining procedure is used to demonstrate acid fastness of the bacteria. With this stain, M. tuberculosis stains bright red, while the tissue cells and other organisms are stained blue.
Culture
M. tuberculosis is an obligate aerobe and characteristically grows very slowly in media. Optimum temperature is 37oC, and the bacteria do not grow below 25oC or above 40oC. Optimum pH is 6.4-7.0. M. bovis is microaerophilic on primary isolation, which subsequently becomes aerobic on subculture.
Biochemical Reactions
M. tuberculosis is usually catalase positive. It is amidase positive. It produces amidase enzymes, such as nicotinamidase and pyrazinamidase,
which split various amide substrates.
M. tuberculosis is positive for nitrate reduction test but arylsulfate test negative.
Mycobacteria are killed by heating at 60oC for 15-20 minutes. Killing of the bacteria is dependent on the nature of the clinical specimen in which the bacteria are present. Mycobacteria in the sputum may survive for 20-30 hours, but in dried sputum protected from the sunlight they may survive longer, up to 6 months.
Pathogenesis and Immunity
M. tuberculosis causes tuberculosis, a classic mycobacterial disease in humans.
Virulence factors
The capability of M. tuberculosis for intracellular growth in alveolar macrophages is the main determinant of virulence of the bacteria. M. tuberculosis does not produce any toxin. Although cord factor and sulfolipids are toxic substances produced by mycobacterium, their existence as virulence factors is doubtful.
Tuberculosis may be primary or postprimary depending on the time of infection and the type of host immune response. Primary tuberculosis: Primary tuberculosis represents the initial infection caused by M. tuberculosis in an infected host. This condition is usually seen in young children in endemic countries like India. Majority of the inhaled bacteria are killed by the natural defensive mechanisms of the upper respiratory tract. The bacilli that survive these defensive mechanisms reach the lungs and enter alveolar macrophages. Multiplication inside the cells leads to destruction of the cells and release of mycobacteria. This is followed by further cycles of phagocytosis of bacteria by macrophages, multiplication of mycobacteria, and lysis of macrophages. Postprimary (secondary) tuberculosis: Postprimary tuberculosis is caused either by reactivation of latent infection or by exogenous reinfection. Reactivation of primary lesion occurs more commonly in patients with decreased immunity, such as patients receiving transplants, those infected with human immunodeficiency virus (HIV), and in the elderly patients.
Tubercle: Tubercle is the key pathology in tuberculosis. This is an avascular granulomatous condition. It is composed of a peripheral zone of lymphocytes and fibroblasts and a central zone consisting of giant cells with or without caseation. The lesions are mainly of two types: (a) exudative and (b) productive tubercular lesions.
Tuberculin hypersensitivity reaction: This was first described by Robert Koch in experimentally infected animals, such as guinea pigs. Demonstration of this tuberculin reactivity in guinea pigs is known as Koch's phenomenon.
Koch phenomenon is demonstrated by subcutaneous injection of pure culture of virulent tubercle bacilli in a normal guinea pig. Initially, no immediate visible reaction is observed at the site of inoculation in the guinea pigs. But after 10-14 days, a hard nodule appears at the site of inoculation, which soon breaks down to from an ulcer that persists till the animal dies of progressive tuberculosis. The regional lymph nodes draining the region become enlarged and caseous. In contrast, when a guinea pig already inoculated 4-6 weeks earlier by tubercle bacilli is injected with tubercle bacilli, an individual lesion develops at the site of second inoculation within 24-48 hours. The lesion undergoes necrosis in another day to produce a shallow ulcer that heals rapidly.
Humoral immunity is characterized by the development of antibodies in serum, but they do not play any role in conferring immunity against the bacteria.
Tuberculin test: Tuberculin test is performed to demonstrate delayed type IV or cell-mediated hypersensitivity reaction to tubercle bacilli. Originally, the tuberculin test was performed by using a protein known as old tuberculin (OT) prepared by Robert Koch.
Clinical Manifestations
The clinical manifestations of tuberculosis depend on the site of infection. However, primary infection is usually pulmonary. M. tuberculosis produces following clinical syndromes: (a) pulmonary tuberculosis and (b) extrapulmonary tuberculosis.
Pulmonary tuberculosis
Productive cough, fever, and weight loss are typical symptoms of pulmonary tuberculosis. Hemoptysis or chest pain, night sweats, fatigue, and anorexia are the other systemic manifestations. The sputum may be scanty or bloody and purulent and, as a result, is usually associated with cavitary lesions in the lung.

Extrapulmonary tuberculosis
Depending on the site of infection, extrapulmonary infections may be:
- Genitourinary tuberculosis -one of the most common extrapulmonary manifestations of tuberculosis.
- Tubercular meningitis - This is one of the most severe complications of tuberculosis.
- Gastrointestinal tuberculosis
- Skeletal tuberculosis
- tubercular lymphadenitis
Tuberculosis with HIV
Patients with tuberculosis should be tested for HIV and those with HIV need to be tested periodically for tuberculosis by tuberculin skin test and chest radiography. HIV patients with a positive tuberculin skin test (TST) usually develop active tuberculosis at a rate of 3-16% per year. HIV reactivates latent tuberculosis infection, makes the disease more serious, and renders treatment ineffective.
Epidemiology
Tuberculosis is the number one infectious killer disease worldwide.
One-third of the world population is infected with M. tuberculosis. Nearly, two-thirds of all cases of tuberculosis occur in the developing countries including India, Pakistan, China, Bangladesh, Philippines, Indonesia, Thailand, and Congo. Nearly, 3 million people die of tuberculosis every year and nearly 2 billion people have latent tuberculosis. Tuberculosis is a major health problem in India. More than 40% of the population is infected with M. tuberculosis, and nearly 15 million people suffer from tuberculosis of which 3 million people are highly infectious open cases of tuberculosis. Nearly half a million people die from the disease every year.
Human beings are the only source and reservoir for M. tuberculosis infection. The infectiousness of the source is of primary importance, which determines the possibility of transmission of the disease. M. bovis infection is transmitted to humans by ingestion of raw milk of the cows infected with M. bovis. The infection among animals is spread by aerosolized bacilli in moist cough sprays. The infected animals usually excrete the bacilli in their milk. Person-to-person transmission of M. bovis usually does not occur.
HIV is one of the most important risk factor. Case rates for individuals who are infected with both HIV and M. tuberculosis exceed the infective risk of individuals with M. tuberculosis infection who are not infected with HIV.
Diagnosis
The clinical diagnosis of tuberculosis is supported by laboratory diagnosis and other tests including radiographic evidence of pulmonary disease. Definitive diagnosis of tuberculosis is made by detection of M. tuberculosis from clinical specimens by microscopy or culture.
Sputum is the specimen of choice for pulmonary tuberculosis. Sputum, not saliva, is collected in the morning into a clean wide-mouthed container, such as sputum cup. Other specimens may be more appropriate for extrapulmonary tuberculosis. These include urine, gastric aspirate, CSF and Pleural fluid.
Specimen collected can be used for microscopy or for culture
Tuberculin skin test: Tuberculin skin test (TST) is a widely used test for diagnosis of tuberculosis. It is also valuable to measure prevalence of tuberculosis infection in a community.
With the emergence of multidrug resistant (MDR) mycobacteria, determination of drug susceptibility testing is important for starting appropriate treatment. Drug susceptibility can be demonstrated by both (a) phenotypic susceptibility assays and (b) genotypic methods.
The conventional diagnostic methods are very slow and time consuming and require 6-8 weeks for isolation of M. tuberculosis. Hence, recently more rapid and automated methods are being increasingly used for diagnosis of tuberculosis. These recent methods include automated radiometric culture methods (e.g., BACTEC), SEPTICHEK, mycobacterial growth indicator tubes (MGITs), etc.
Treatment
Antituberculous drugs are classified as first-line and second-line drugs.
First-line antitubercular drugs
First-line antitubercular drugs include rifampicin, INH, ethambutol, streptomycin, and pyrazinamide. All first-line drugs with the exception of ethambutol are bactericidal.
Combination of four drugs (INH, rifampicin, pyrazinamide, and ethambutol) is given for a period of 6-7 months for treatment of smear-positive cases of tuberculosis. These are given three times a week for first 2 months, followed by only two drugs (INH, rifampicin) three times a week.
Second-line antitubercular drugs
Second-line antitubercular drugs are used for the cases of tuberculosis where first-line drugs become ineffective. These include a large number of old and new drugs, such as ciprofloxacin, cycloserine, ethionamide, kanamycin, ofloxacin, levofloxacin, capreomycin, and others.
Prevention and Control
Chemoprophylaxis: Chemoprophylaxis or preventive chemotherapy is carried out by use of antitubercular drugs, such as INH.
Vaccination against tuberculosis is carried out by administration of the vaccine. BCG is a live attenuated vaccine prepared from attenuated strain of M. bovis.
Prevention of tuberculosis can also be implemented through general health measures including adequate nutrition, good housing, and health education.
Nontuberculous Mycobacteria
Nontuberculous mycobacteria (NTM) are the mycobacteria
other than the tubercle and lepra bacilli. These are also known
as mycobacteria other than tubercle bacilli (MOTT). MOTT are classified as rapid growers and slow growers: Mycobacterium fortuitum, Mycobacterium chelonae, and Mycobacterium abscessus are the examples of more rapidly growing Mycobacterium species, which require incubation for 3 days
or more for development of the colonies.
Mycobacterium avium-intracellulare complex and Mycobacterium
kansasii are the slow-growing Mycobacterium species and
require 3-8 weeks of incubation for their growth.
Mycobacterium leprae and Mycobacterium lepraemurium
Mycobacterium leprae
Mycobacterium leprae is the causative agent of leprosy, a chronic granulomatous disease primarily affecting the skin and peripheral nervous system. M. leprae was the first bacterial pathogen to be associated with a specific human disease and the only mycobacterium known to cause infection of the nervous tissue. The Koch's postulates have never been fulfilled for M. leprae, because so far it has not been cultivated in vitro.
Morphology
M. leprae is less acid fast than Mycobacterium tuberculosis. Hence 5% sulphuric acid, instead of 20%, is used for decolourization after staining with carbol fuchsin. It is Gram positive and stains more readily than M. tuberculosis. It is a straight or slightly curved rod with parallel sides and rounded ends. It measures 1-8 µm in length and 0.2-0.5 µm in diameter, showing considerable morphological variations. The bacteria exhibit cubical, lateral, or even branching forms. M. leprae is an obligate intracellular bacterium that multiplies preferentially in tissues at cooler temperature. M. leprae are nonmotile and nonsporing.
M. leprae remains viable in warm humid environment for 9-16 days and in moist soil for 46 days. They also remain viable on exposure to ultraviolet light for 30 minutes and to direct sunlight for 2 hours.
Pathogenesis and Immunity
Leprosy is a chronic granulomatous disease exclusively of humans. Superficial peripheral nerves, skin, mucous membranes of the upper respiratory tract, anterior chamber of the eye, and testis are most commonly affected.
Virulence factors M. leprae is an obligate intracellular acid-fast bacillus with an affinity for macrophages and Schwann cells. The virulence of M. leprae is mainly due to its capabilities for intracellular multiplication and growth, and the Host's immune system that influences the clinical form of the disease.
Leprosy is primarily transmitted by infected nasal secretions. Infections by a very large number of lepra bacilli lead to lepromatous leprosy. A strong cell-mediated response, however, results in mild form of the disease with low bacterial load and involvement of only few nerves. Skin and peripheral nerves are commonly involved in leprosy. Although bacilli are also found in the liver, spleen, and bone marrow, no clinical signs of dysfunction of these visceral organs are noted. The destructive lesions in leprosy, even in most advanced cases, are limited to the peripheral nerves, skin, and upper respiratory passages above the larynx, anterior chamber of the eye, testis, hands, and feet.
The clinical manifestations of leprosy depend on the immune status of the host and spread of the bacilli. It is classified into five groups as: (a) tuberculoid leprosy, ( b) borderline tuberculoid leprosy, (c) mid-borderline leprosy, (d) borderline lepromatous leprosy, and (e) lepromatous leprosy. The incubation period varies from 6 months to 40 years or longer. The mean incubation period for tuberculoid leprosy is 4 years and for lepromatous leprosy is 10 years.
Epidemiology
Leprosy is most endemic in Brazil, Angola, Central African Republic, Congo, Madagascar, Mozambique, Tanzania, Nepal, and India. Approximately 74% of these cases are found in these nine countries. Lepromatous leprosy is more prevalent in Africa, while tuberculosis is more frequent in Asia. In India, leprosy is present in all states and territories. Overall, the prevalence of the disease has decreased since the introduction of short multidrug therapy in 1982.
Leprosy is an exclusively human disease. Humans are the prime reservoir of M. leprae. Nine-banded armadillo, chimpanzee, and mangabey monkeys are the three animal species known to be important animal reservoirs of leprosy. Leprosy is not a highly infectious disease. Nasal secretions from patients with lepromatous leprosy are important source of infection. Very large numbers of lepra bacilli are shed in the nasal secretions.

Diagnosis
In lepromatous leprosy, lepra bacilli are always found in large numbers in the skin and in the nose. Therefore, smears collected from the nasal mucosa, skin lesions, and ear lobules are the specimens of choice for microscopy.
The lepromin test is used to study host immunity to M. leprae. The test was first described by Mitsuda in 1919. The test is an intradermal skin test performed by using lepromin antigen, which is a suspension of killed M. leprae obtained from infected human or armadillo tissue.
Serodiagnosis of leprosy is based on demonstration of antibodies to M. leprae, specific PGL-1 antigens. Enzyme linked immunosorbent assay (ELISA) and latex agglutination test are used to detect serum antibodies.
Treatment
Chemotherapy The goals of chemotherapy against leprosy are to (a) stop infection, (b) reduce morbidity, (c) prevent complications, and (d) eradicate the disease.
Multiple drug therapy (MDT) against leprosy: The MDT quickly decreases contagiousness of the disease, reduces relapse and reactions, and reduces disabilities. Moreover, MDT prevents dapsone resistance. The duration of treatment varies from 6 months to 2 years.
Prevention and Control
The preventive and control measures include: (a) early diagnosis and treatment of leprosy and surveillance of contacts, (b) health education, (c) vaccines, and (d) chemoprophylaxis.
Mycobacterium lepraemurium
M. lepraemurium and M. leprae are not related species, and they differ from each other as shown by DNA studies. M. lepraemurium in rats causes rat leprosy, which is characterized by two forms: glandular form and musculocutaneous form. Enlarged, hard, and whitish inguinal, axillary, and cervical lymph nodes are found in the glandular type, and ulceration and loss of hair are found in the musculocutaneous type. The bacteria do not cause disease in humans.
Treponema, Borrelia, and Leptospira
The order Spirochaetales is subdivided into two families: Spirochaetaceae and Leptospiraceae. The family Spirochaetaceae consists of four genera: Spirochete, Cristispira, Treponema, and Borrelia. The genera Treponema and Borrelia include pathogenic species, which cause diseases in humans. Members of the genus Cristispira are found in molluscs, while Spirochetes are saprophytes found in sewage and water. Family Leptospiraceae contains only one genus Leptospira, which consists of species pathogenic to humans.
Treponema
The treponemes are short and slender spirochetes with fine spirals and pointed ends. Some of them are pathogenic for humans, while others occur as commensals in the mouth, intestine, and genitalia. Pathogenic members of the genus include Treponema pallidum and Treponema carateum.
Treponema pallidum
T. pallidum is the causative agent of syphilis, the most common sexually transmitted disease.
Morphology
T. pallidum is a thin, coiled spirochete. It measures 0.1 µm in breadth and 5-15 µm in length. It has six to ten sharp and angular coils, which are present at regular interval of 1 µm. It is actively motile. Endoflagella are responsible for motility of the bacteria. As the Treponema moves, it shows a series of secondary curves, which appear and disappear but its primary spiral structure remains unchanged. T. pallidum is too thin to be seen by microscopy in specimens stained by simple Gram or Giemsa staining. It is stained by silver impregnation method, which makes the bacteria thickened by deposition of silver compounds.
Culture
T. pallidum does not grow in artificial culture media. T. pallidum had been maintained for a long time by subculture in animals.
T. pallidum is a very delicate bacterium. It is readily killed by drying or heating at 41-42oC for 60 minutes, at 0-4oC for 1-3 days. They are also readily killed on contact with distilled water, soap, arsenic compounds, mercuric compounds, bismuth compounds, and common antiseptics.
Pathogenesis and Immunity
T. pallidum is a strict human pathogen and does not naturally occur in any animal species. Humans are the only natural hosts. Infected human hosts secreting T. pallidum in serous transudates from moist lesions, such as primary chancre, condyloma latum, mucous patch, etc., are the sources of infection. Transmission of syphilis occurs primarily through sexual contact by inoculation of the spirochetes through mucosal membranes and abrasions on epithelial surfaces. Vertical transmission transplacentally and vertical transmission of early syphilis during pregnancy results in a congenital infection in at least 50–80% of exposed neonates. Transmission could also occur through transfusion of T. pallidum-contaminated blood.
T. pallidum is antigenically complex. Infection by the bacteria induces production of at least three types of antibodies against (a) cardiolipin antigen, (b) group-specific antigens, and (c) species-specific antigens of T. pallidum.
Virulence factors
The possible virulence factors of T. pallidum include the following:
- Outer membrane proteins: Promote adherence of T. pallidum to the surface of host cells
- Enzyme hyaluronidase: Facilitates perivascular infiltration
- Fibronectin: Prevents phagocytosis of T. pallidum by macrophages
T. pallidum causes disease by invasion and multiplication at the site of infection, then spreading via circulation and producing disseminated disease. On sexual contact, T. pallidum from infected partner is passed to another partner through intact mucous membrane or through minor skin abrasions. The organisms invade the skin at these lesions and multiply at the site of infection.
The treponemes get transmitted in the blood stream and produce disseminated lesions (papular skin rashes, mucous patches in the oropharynx, etc.).
T. pallidum causes the following clinical syndromes:
1. Venereal syphilis (transmitted by sexual contact)
2. Nonvenereal syphilis (congenital syphilis and occupational
syphilis)
Syphilis in persons with human immunodeficiency virus (HIV) infection is a problem increasingly recognized recently. Concomitant HIV and syphilis are common.
Diagnosis
Specimens for microscopy include serous transudates from moist lesions, such as primary chancre, condyloma latum, mucous patch, etc. Serum is used for serodiagnosis, and cerebrospinal fluid (CSF) is used for diagnosis of neurosyphilis.
Treatment
Penicillin is the drug of choice for treatment of all the stages of syphilis. A single intramuscular dose of benzathine penicillin G is effective for treatment of primary, secondary, and early latent syphilis.
Prevention and Control
Avoidance of sexual contact with infected partners avoids transmission of infection. Use of condoms during sexual intercourse or antiseptics (such as potassium permanganate) or prophylactic use of antibiotics may minimize the risk of transmission of the disease.
Nonvenereal Treponematosis
The condition includes three distinct entities, such as endemic syphilis, yaws, and pinta.
Endemic Syphilis
The condition, also known as Bejel in the Middle East, njovera in Zimbabwe, dichuchwa in Bechuanaland, Skerjevo in Eastern Europe, and siti in Zambia, is caused by T. pallidum subspp. endemicum. The condition has also been documented from India. The disease is transmitted from person-to-person by the use of contaminated utensils.
Yaws
The condition also known as Pian, Parangi, etc., is prevalent in the primitive tropical parts of central Africa, South America, and Southeast Asia. The condition is also documented in India from Andhra Pradesh and Madhya Pradesh. The causative agent T. pertenue is morphologically and antigenically similar to T. pallidum. The pathogen causes yaws, which is characterized by an extragenital papule, which subsequently enlarges and breaks down to form an ulcerating granuloma.
Pinta
Pinta, also known as carate, mal del pinto, is caused by T. carateum. and is endemic in Central and South America and the neighboring islands. An extragenital papule is the primary skin lesion observed in the condition. Small pruritic papules develop on surface of the skin after an incubation period of 1–3 weeks. These lesions do not ulcerate, but enlarge and persist for months to years before resolving.
Nonpathogenic Treponemes
Nonpathogenic treponemes are a heterogenous group of treponemes found as commensals on the buccal and genital mucosa. These include Treponema denticola, Treponema macrodentium, Treponema oralis, Treponema socranski, and Treponema pectinovorum.
Borrelia
Borrelia is a genus of bacteria of the spirochete phylum. Some species cause Lyme disease, also called Lyme borreliosis, a zoonotic, vector-borne disease transmitted by ticks. Other species of Borrelia cause relapsing fever, which are transmitted by ticks or lice, depending on the species of bacteria.
Borrelia recurrentis
B. recurrentis is the causative agent of relapsing fever, which manifests as one or more relapses of fever after the subsidence of primary paroxysm of fever.
Morphology
B. recurrentis has an unequal spiral-shaped structure with one or both the ends pointed. It measures 8-20 µm in length and 0.2-0.4 µm in breadth. It possesses 15-20 endoflagella per cell and 5-10 loose uneven spiral coils. The spiral coils are coarser and more irregular than those of treponemes and leptospires. It is Gram negative. It can be stained by Wright and Giemsa stain for demonstration by microscope. It is actively motile in fresh blood preparation.
Culture
Borrelia is microaerophilic. The bacteria grow at optimum temperature of 28-30oC. They have complex nutritional requirements, hence are difficult to grow on artificial media. They can grow in chorioallantoic membrane of chick embryo.
Pathogenesis and Immunity
The ability of B. recurrentis to undergo antigenic shift and escape from immune clearance of the host is the main virulence factor attributed to the bacteria. B. recurrentis penetrates the skin, reaches the blood circulation and invades various organs in the body and cause the disease.
Clinical manifestations of epidemic louse-borne and endemic tick-borne relapsing fever are essentially similar. The incubation period is usually 7 days. Two or more episodes of high fever, headache, and myalgia are the hallmarks of the disease. Splenomegaly and hepatomegaly are the associated symptoms.
Treatment
Tetracycline or erythromycin is most effective for treatment of relapsing fever. Doxycycline is usually recommended for children and pregnant women.
Prevention and Control
Prevention of louse infiltration and the use of insecticide are the measures that prevent louse-borne relapsing fever. Prevention of tick-borne relapsing fever consists of wearing protective clothings, use of insect repellants, and avoidance of ticks and their natural habitat.
No vaccine is available for relapsing fever.
Borrelia burgdorferi
B. burgdorferi, a newly identified Borrelia species, is the causative agent of Lyme disease.
Lyme disease is a tick-borne disease transmitted to humans by ixodid ticks. The incubation period varies from 7 to 14 days. After bite of the tick, B. burgdorferi is inoculated through the skin and then spreads locally. The local spread of the bacteria causes erythema migrans, a rash seen in approximately two thirds of the cases.
This disease is characterized by the presence of multiple erythema migrans, systemic complications (fever, myalgias, arthralgia, malaise, and headache) and even septic meningitis; this disease usually develops 3–10 weeks after the tick bite.
Lyme disease is a zoonotic disease. Rodents, bear, and other mammals are the natural reservoir hosts. Hard ticks (ixodid ticks) are the vectors of the disease.
Amoxicillin, tetracycline, cefuroxime, or ceftriaxone are effective for the treatment of Lyme disease. Avoidance of exposure to ticks and use of insecticides are the useful methods for prevention of the disease.
Leptospira
The leptospires belong to the genus Leptospira, the family Leptospiraceae, and the order Spirochaetales.
Leptospira interrogans Complex
L. interrogans complex includes pathogenic leptospires that cause leptospirosis. The disease, often referred to as swamp fever, mud fever, or swine herd's disease, is the most common zoonosis in the world.
Morphology
L. interrogans are thin, delicate, coiled spirochetes measuring 6-20 µm length and 0.1 µm in breadth. They are actively motile by means of two periplasmic flagella, each present at opposite end of the bacteria by continually spinning on the long axes. They possess tightly coiled spirals and hooked ends, resembling the handle of an umbrella.
Culture
L. interrogans are obligate aerobes. They use fatty acids and alcohols as source of carbon and energy. They grow at an optimum temperature of 25-30oC and optimum pH of 7.2-7.5.
Leptospira are readily killed by heating at 50oC for 10 minutes and at 60oC for 10 seconds. They are destroyed by acidity of gastric juice in 30 minutes and also by the bile. They are also readily destroyed by chlorine and commonly used antiseptics and disinfectants.
Clinical Syndromes
L. interrogans causes leptospirosis, which occurs as two recognizable clinical syndromes as anicteric leptospirosis and icteric leptospirosis.
Approximately, 90% of infections with L. interrogans manifest as a mild anicteric (absence of jaundice) form of the disease. These clinically inapparent infections are diagnosed only by demonstration of specific leptospira antibodies in the patient serum. Approximately 10% of the patients develop icteric manifestations of the disease, otherwise known as Weil's disease. The disease is characterized by the development of jaundice.
Treatment
Oral doxycycline is the drug of choice for treatment of uncomplicated Leptospira infection, not requiring hospitalization. Intravenous penicillin or ampicillin is recommended for hospitalized patients. Streptomycin, tetracycline, or erythromycin is indicated for patients allergic to penicillin.
Prevention and Control
Preventive measures include detection of cases and detection of common source of infection. Disinfection of water supplies, rodent control, and wearing of protective clothings control transmission of the disease. Leptospire infection in livestock is controlled by improved sanitation, immunization of animals, and proper veterinary care. Recently, human vaccines are available against leptospirosis. These vaccines are recommended only for high-risk workers.
Mycoplasma and Ureaplasma
The family Mycoplasmataceae includes parasite mycoplasmas, which require cholesterol or other sterols as growth factors. It consists of two genera; Mycoplasma and Ureaplasma. At least 13 species of genera Mycoplasma and Ureaplasma are known to colonize or cause diseases in humans
The genus Mycoplasma contains the pathogens that use glucose or arginine, but do not utilize urea. Mycoplasma pneumoniae is the most important species known to cause infection in humans. Mycoplasma hominis, Mycoplasma fermentans, Mycoplasma pirum, Mycoplasma salivarium, Mycoplasma orale, and Mycoplasma genitalium are the other pathogens that are commonly associated with human infections.
The genus Ureaplasma includes the organisms that utilize urea. Ureaplasma urealyticum is the most important species isolated from infections of genital and respiratory tract in humans.
Mycoplasmas differ from prokaryotes by having a unique cell membrane that contains sterols. Also, the mycoplasmas do not have a cell wall. Mycoplasma pathogens when first discovered were thought to be viruses
Mycoplasma pneumoniae
M. pneumoniae is the most important species causing upper respiratory tract disease.
Morphology
Mycoplasmas are very small bacteria measuring 150-250 nm. They do not have a cell wall and typically their cell membranes contain sterols. Many mycoplasma can pass through 0.45 µm filter, hence were once believed to be viruses. However, they differ from viruses because they contain both ribonucleic acid (RNA) and deoxyribonucleic acid (DNA), they are able to grow on cell-free media in vitro, and they show both intracellular and extracellular parasitism in vivo. The absence of cell wall makes Mycoplasma resistant to penicillins, cephalosporins, vancomycin, and other antibiotics that interfere with the synthesis of the
Mycoplasma species typically show pleomorphism and occur as granular and filaments of various sizes.
They do not possess flagella or pili, but some Mycoplasma species including M. pneumoniae show gliding motility on liquid-covered surfaces. Mycoplasma organisms stain poorly by Gram stain and are Gram negative. They are better stained by Giemsa and Diene stain.
Culture
Mycoplasmas are aerobic and facultative anaerobes. M. pneumoniae is an exception, which is a strict aerobe. They grow at 37oC and at pH range of 7.3-7.8. M. pneumoniae unlike other Mycoplasma species are very slow-growing bacteria. They require 1-4 weeks to produce colonies on agar.
M. pneumoniae does not produce fried-egg appearance colonies but instead produces a colony known as mulberry shaped
Most Mycoplasma colonies produce a zone of hemolysis on blood agar.
M. pneumoniae and other species (M. fermentans, M. genitalia, and M. agalactiae) utilize glucose and other carbohydrates as the major source of energy. M. salivarium and other species (M. orale, M. hominis, and M. fermentans) utilize arginine as a major source of energy. Mycoplasma are chemo-organotrophs, the metabolism being mainly fermentative.
Mycoplasmas are readily killed by heating at 56oC for 30 minutes. The bacteria are sensitive to antiseptic solutions, such as cycloheximide and cetrimide, which inhibit their growth. They are resistant to UV light
Pathogenesis and Immunity
Mycoplasmas are primarily extracellular pathogens that adhere to surface of ciliated and nonciliated epithelial cells.
Virulence factors
The adhesion protein called P1 is the key virulence factor of the Mycoplasma. The bacteria usually do not cause invasion of the blood to produce systemic manifestation of the disease.
After adhering to the epithelium, Mycoplasma cause direct damage to the epithelial cells in which first cilia and then ciliated epithelial cells are destroyed. Loss of the cells interferes with normal functioning of the upper respiratory tract. This results in the lower respiratory tract to become infected with microbes and mechanically irritated. The mechanical irritation causes persistent cough typically seen in patients with respiratory infection caused by M. pneumoniae.
M. pneumoniae behaves as a super antigen. This causes migration of inflammatory cells to the site of infection and produces cytokines, which help in clearing the bacteria and the disease.
Respiratory infections: Majority of the respiratory infections are mild and self- limiting. M. pneumoniae causes (a) upper respiratory tract infections, (b) lower respiratory tract infections, and (c) primary atypical pneumonia
Epidemiology
M. pneumoniae infection is distributed worldwide. The organism is responsible for up to 20% of community-acquired pneumonia, which requires hospitalization. M. pneumoniae infection occurs both in epidemic and in endemic forms. umans are the usual host of M. pneumoniae and thus significant reservoir of infection.
The infection is transmitted by inhalation of aerosolized droplets. Person-to-person transmission usually occurs among college students and military recruits who live together in close proximity. M. pneumoniae is usually associated with pneumonia, and highest rate of infection is found in children between 9 and 10 years, and also in young adults. Infection is common among school-going children. n recent years, the infection is also being increasingly documented in people older than 65 years. In this old population, M. pneumoniae is responsible for causing nearly 15% of community-acquired pneumonia, second only to Streptococcus pneumoniae as a cause of pneumonia.
Diagnosis
Respiratory specimens include throat washings, bronchial washings, and expectorated sputum. Tracheal washings are more useful than sputum specimens, because most patients with respiratory tract infections do not produce any sputum as they have a dry and nonproductive cough. The specimens are collected and transported to the laboratory immediately.
Microscopy is of no value in diagnosis of M. pneumoniae infections. Mycoplasmas are stained poorly due to their lack cell wall.
Serodiagnosis is based on demonstration of specific antibodies in serum using Mycoplasma antigens.
Treatment
Therapy with antibiotics is usually not necessary for treatment of upper respiratory tract infection caused by M. pneumoniae. However, treatment with antibiotics may be helpful for management of Mycoplasma pneumonia, because it reduces duration of illness and also reduces the number of Mycoplasma in clinical specimen. It also reduces the symptoms, enhances resolution of pneumonia, and facilitates recovery from the disease. Pneumonia is usually a self-limiting disease and is not life-threatening in most patients.
M. pneumoniae remains susceptible to tetracyclines and erythromycin, because these antibiotics act on the mycoplasmas by inhibiting synthesis of protein. Tetracycline has the additional advantage of also being active against most other mycoplasmas and chlamydiae, the common causes of nongonococcal urethritis.
Prevention and Control
Isolation of the patients infected with M. pneumoniae is the best way to prevent the spread of the disease. Antibiotic prophylaxis with tetracyclines or erythromycin is also useful. No vaccine is available against Mycoplasma infections.
Genital Mycoplasma Species
M. hominis and Mycoplasma genitalis are the genital Mycoplasma species, which inhabit the mucosa of the urogenital tract.
Mycoplasma hominis
M. hominis is a facultative anaerobe and is relatively fast-growing with growth observed within 1-4 days. The bacteria metabolize arginine but do not utilize glucose. It typically produces large fried-egg appearance colonies on Mycoplasma medium.
M. hominis is associated with infection of genitourinary tract and reproductive disease. M. hominis causes genital infection, which may result in diverse manifestation, such as salpingitis, pelvic abscess, puerperal infection, septic abortion.
Mycoplasma genitalis
M. genitalis has also been implicated as a cause of nongonococcal urethritis and pelvic inflammatory disease (PID). M. genitalis is primarily a pathogen of the gastrointestinal tract, which can cause occasional infection in the genitourinary and respiratory tract. It is a very difficult organism to be isolated by culture. Their isolation may require more than 2-4 months of incubation.
Ureaplasma urealyticum
U. urealyticum is a genital pathogen, which is associated with the urogenital tract of humans and animals. It is one of the most important causes of nongonococcal urethritis.
U. urealyticum is a sexually transmitted pathogen and causes chorioamnionitis, prematurity, vaginitis, cervicitis, acute salpingitis, and pelvic inflammatory disease in women. Ureaplasma organisms are most frequently isolated from infants, particularly girls. The bacteria also cause urethritis, proctitis, balanoposthitis, and Reiter's syndrome in men.
Actinomycetes
Actinomycetes include a wide range of bacteria, which are found in soil and putrefied vegetables. They are also found in humans and animals. The actinomycetes include anaerobic or facultative anaerobic bacteria belonging to the genus Actinomyces. They can be classified into two groups:
- Actinomycetes with mycolic acids: This group includes members of three families: Corynebacteriaceae, Mycobacteriaceae, and Nocardiaceae
- Actinomycetes without mycolic acid: This group includes many opportunistic pathogens, such as Actinomadura, Nocardiopsis, Streptomyces, Dermatophilus, Oerskovia, Rothia, Tropheryma, and thermophilic actinomycetes - Saccharopolyspora, Saccharomonospora, and Thermoactinomyces.
Actinomyces
Actinomyces israeli is the most common Actinomyces causing human infection.
Actinomyces organisms are Gram-positive, nonmotile, nonsporing, and non-acid-fast bacilli. They measure 0.5-1 µm in diameter. They often grow in filaments that separate into bacillary and coccoid filaments.
Culture
Actinomyces organisms are facultative anaerobes. They grow better under anaerobic or microaerophilic conditions at an optimum temperature of 35-37oC. Presence of 5-10% CO2 facilitates the growth. Actinomyces species grow slowly; they need a longer incubation period of 3-4 days. A. israeli may require even 7-14 days for growth
Pathogenesis and Immunity
Actinomyces species are present as normal flora of the oral cavity and also in the lower gastrointestinal tract and female genital tract of human hosts. Some companion bacteria are believed to act as copathogens that enhance the virulence of Actinomyces. These include Bifidobacterium dentium, Actinobacillus actinomycetemcomitans, Eikenella corrodens, Haemophilus aphrophilus, Bacteroides, Fusobacterium, staphylococci, and anaerobic streptococci.
Once infection occurs, the immune system of the infected human host stimulates an intense inflammatory response in the form of a suppurative granulomatous and fibrotic reaction.
Actinomycosis
Actinomycosis is a subacute and chronic bacterial infection characterized by contiguous spread and suppurative and granulomatous inflammation. The condition is associated with the formation of multiple abscesses and development of sinus tracts discharging white to yellowish granules, known as sulphur granules
Epidemiology
Actinomycosis is distributed worldwide. The condition is more common in rural areas and in farm workers. The condition is seen more commonly in individuals with poor dental hygiene and in the people with low socioeconomic conditions. Men are affected more commonly than women.
Diagnosis
The specimens include sputum, bronchial secretions and discharges, and infected tissues. All these specimens may contain large number of sulfur granules. The sulfur granules are also present on the dressings removed from a draining sinus tract. It is essential to transport these specimens immediately to the laboratory for processing, preferably under anaerobic conditions.
Treatment
High-dose penicillins or tetracyclines given over a prolonged period are the mainstay of therapy for actinomycosis. Metronidazole, cotrimoxazole, and sulfamethoxazole, and penicillinase-resistant penicillins, such as methicillin, oxacillin, and cloxacillin do not have activity against Actinomyces species.
Actinomycosis can be prevented through good dental hygiene and oral hygiene .
Nocardia
Nocardia are aerobic actinomycetes that are ubiquitous in the soil, decaying organic matter, and water.
Nocardia infection was first described by French veterinarian Edmund Nocard in a pulmonary and cutaneous disease of cattle. The genus Nocardia is named so in honor of the scientist.
The genus Nocardia has been classified into 10 species on the basis of phylogenetic analysis of 16S rRNA
Morphology
Nocardia are Gram-positive bacilli showing a branching, beaded, and filamentous form. They stain poorly with Gram stain and appear to be Gram negative with intracellular Gram-positive granules. Nocardia organisms like that of mycobacteria contain mycolic acid in their cell wall. They are usually weakly acid fast. Acid fastness is a property of Nocardia by which it can be differentiated from other similar bacteria, such as actinomycetes.
Culture
Norcadia are strictly aerobic bacteria. They readily grow on commonly used routine media, such as nutrient agar, Sabouraud's dextrose agar, BHI agar, and yeast extract malt extract agar. Presence of 5-10% of CO2 facilitates the growth of the bacteria. Norcadia are slow-growing bacteria and, therefore, need prolonged incubation of 7 days or more for their culture and isolation in the media. Norcadia on these media produces colonies varying from dry to waxy and white to orange in color.
Biochemical Reactions
Nocardia are catalase positive and they use sugars oxidatively. They produce acid from glucose and they utilize urea.
Pathogenesis and Immunity
Nocardia species are opportunistic pathogens. Nocardia causes suppurative necrosis with the formation of abscesses at the site of infection. Nocardia can manifest as:
- Cutaneous nocardiosis: arises from the local trauma on the skin, which facilitates entry of the organism into subcutaneous tissues.
- Pleuropulmonary disease: occurs most commonly due to inhalation of infectious aerosols.
Epidemiology
Nocardial infections are reported worldwide, but no reliable estimates are available.
Diagnosis
Nature of the clinical specimens depends on clinical presentation of nocardiosis. Sputum is a frequently used specimen. Other specimens include respiratory secretions, skin biopsies, or pus from the abscesses.
Treatment
Sulfonamides are the drug of choice for the treatment of nocardiosis. Sulfadiazine is useful for treatment of CNS infections. Trimethoprim and sulfamethoxazole are considered better than sulfadiazine. Nocardia are also susceptible to carbapenems, such as imipenem and cilastatin, cefotaxime or ceftriaxone and amikacin.
Prevention and Control
Prophylactic antibiotic therapy with trimethoprim and sulfamethoxazole has been shown to be of some value in prevention of the disease.
Rhodococcus
The genus Rhodococcus organisms are Gram-positive and strict aerobic actinomycetes. The cell wall of Rhodococcus organisms is similar to those of mycobacterium by containing mycolic acid and tuberculostearic acid, which makes the bacteria acid fast.
Rhodococcus equi, formerly known as Corynebacterium equi, is the most important human pathogen. R. equi is a pleomorphic Gram-positive coccobacillus showing some degrees of branching. It is weakly acid fast.
The bacteria cause invasive pulmonary disease, such as pneumonic and lung abscess. Subsequently, the infection may spread to distant sites of the body causing meningitis, pericarditis, etc
Gordonia and Tsukamurella
Genera Gordonia and Tsukamurella are usually present in soil. They were earlier classified with Rhodococcus, because of their morphological similarities to it. These bacteria contain mycolic acid in their cell wall and are acid fast. Genus Gordonia organisms are rare opportunistic pathogens, which cause infection in humans. They have been associated with pulmonary and cutaneous infections. Tsukamurella has been associated with catheter infections.
Tropheryma whippelii
Tropheryma whippelii is an actinomycete known to cause Whipple's disease. The bacterium is yet to be cultured. Whipples disease manifests as abdominal pain, diarrhea, fever, lymphadenopathy, pigmentation of the skin, and arthralgia.
Dermatophilus
Dermatophilus is an actinomycete that causes an exudative dermatitis affecting skin of the hands and feet. The condition is commonly seen in individuals who are in close contact with infected animals or contaminated animal products.
Oerskovia
Oerskovia is an actinomycete that causes opportunistic infection in humans. The bacterium is associated with cervicofacial infections, catheter-associated bacteremia, traumatic endophthalmitis, CNS shunt infections, and infection in patients undergoing long-term peritoneal dialysis.
Rickettsia, Orientia, Ehrlichia and Coxiella
Rickettsiae are obligate, intracellular, very small, Gram-negative bacilli that multiply within cytoplasm of eukaryotic cells.
Rickettsiae are primary pathogens of arthropods, such as lice, fleas, ticks, and mites. In these hosts, they are found in their intestinal tract. They are usually transmitted to humans by arthropod vectors, such as lice, mites, ticks, etc. Coxiella burnetii causing Q fever is an exception, which is transmitted usually by airborne droplets. They also infect humans in whom they are found in the reticuloendothelial cells and vascular endothelium
| Bacteria | Disease/syndrome |
|---|---|
| Rickettsia prowazekii | Epidemic or louse-borne typhus; relapsing louse-borne typhus or Brill-Zinsser's disease |
| Rickettsia typhi | Endemic or flea-borne murine typhus |
| Rickettsia rickettsiae | Rocky Mountain spotted fever |
| Rickettsia rickettsiae | Rocky Mountain spotted fever |
| Rickettsia akari | Rickettsial pox |
| Rickettsia conori | Boutonneuse fever (i.e., Kenya tick bite fever, African tick typhus, Mediterranean spotted fever, Indian tick typhus, and Marseilles fever) |
| Orientia tsutsugamushi | Scrub typhus |
| Ehrlichia sennetsu | Sennetsu fever |
| Ehrlichia chaffeensis | Monocytic ehrlichiosis |
| Ehrlichia phagocytophila | Human granulocytic ehrlichiosis |
| Coxiella burnetii | Q fever |
| Rickettsia australis | Queensland tick typhus |
| Rickettsia sibirica | North Asian tick typhus |
Rickettsia
Rickettsia organisms cause a wide variety of diseases varying considerably in severity from self-limiting illness to fulminating, life-threatening infection.
They are small, Gram-negative coccobacilli varying from 0.3-0.6 to 0.8-2 µm in size. They are nonmotile and noncapsulated. They are stained poorly with Gram stain
Rickettsiae cannot grow on cell-free media. They grow on HeLa, Hep2, Detriot-6, mouse fibroblasts, and other continuous cells lines. In the developing chick embryo 5-6 days old, Rickettsia spp. grow well in the yolk sac.
The extracellular Rickettsia organisms are very delicate microorganisms. They are rapidly killed by heating at 56oC and also at room temperature. They are destroyed by usual strength of antiseptics, such as hypochlorite, 1% ethanol, 2% formaldehyde, 5% hydrogen peroxide, and 70% ethanol.
Rickettsia prowazekii
R. prowazekii is the causative agent of epidemic typhus, also called louse-borne typhus. This condition is an acute febrile illness transmitted by human body louse Pediculus humanus corporis. R. prowazekii is named after the scientist Von Prowazek who died of the typhus fever while studying the disease. This typhus fever is an ancient disease and has been reported from all parts of the world. This disease was widely prevalent in Russia and in Eastern Europe. This disease was also responsible for Napolean's defeat in Russia in 1812. This was one of the three diseases responsible for misery and sufferings during the Irish famine of 1845-1850
R. prowazekii is an invasive bacterium, which characteristically multiplies in endothelial cells of the blood vessels, leading to vasculitis. The process may end in thrombosis and development of small nodules. Thrombosis of supplying blood vessels may cause gangrene of the extremities, ear lobes, nose, and genitalia. The vasculitis process also may result in increased vascular permeability with consequent edema, loss of blood volume, hypoalbuminemia, reduced osmotic pressure, and hypotension.
Epidemic typhus is present in Central and South America, Africa (Ethiopia and Nigeria), Northern China, and in India.
Diagnosis of rickettsial diseases, including epidemic typhus caused by R. prowazekii, is made by isolation of rickettsia in animal models or by serological tests.
Tetracycline and chloramphenicol are the drugs of choice for the treatment of epidemic typhus. Antibiotic therapy in combination with treatment of louse infestation of the human host is effective.
The disease may be controlled by controlling human lice population and sanitation.
Rickettsia typhi
R. typhi is the causative agent of endemic or murine typhus, which is a milder disease than the epidemic typhus and has a shorter duration. The condition has a sudden onset of symptoms with fever, headache, malaise, and myalgia. A rash develops on third to fifth day of infection. The rash is typically present on the chest and abdomen but may spread to palms and soles. Untreated course of the disease may last up to 3 weeks.
Tetracycline, doxycycline, and chloramphenicol are highly effective in the treatment of endemic typhus.
Rickettsia rickettsiae
R. rickettsiae causes Rocky Mountain spotted fever, the most serious type of spotted fever.
R. rickettsiae like other rickettsiae multiply within the endothelial cells of the small blood vessels and invade the blood streams. Subsequently, they cause vasculitis and vascular lesions, which are found in almost all organs but are commonly found in the skin and in the adrenal glands, liver, heart, and CNS. The condition is characterized by development of fever, severe headache, chills, and myalgia. A rash may develop after three or more days and typically appears initially on wrist, ankles, and palms and soles and then spreads to the trunk. The rash is maculopapular early in the disease but may later become petechial and hemorrhagic.
Tetracyclines, chloramphenicol, and fluoroquinolones, such as ciprofloxacin are effective against R. rickettsiae.
The use of protective clothing and insect repellents and avoidance of tick-infested areas are preventive measures against R. rickettsiae infection. No vaccine is available against the Rocky Mountain spotted fever.
Orientia
The genus Orientia contains Orientia tsutsugamushi, the causative agent of scrub typhus. The condition is transmitted to humans by the mite Leptotrombidium akamushi and also possibly by Leptotrombidium deliense. O. tsutsugamushi shows a remarkable antigenic heterogeneity. Three major serotypes are recognized. These are Kart, Gili, and Kata types. Scrub typhus is restricted in its geographical distribution. The condition is present in the western Pacific regions, Australia, and Eastern Asia. Once the mice are infected, they act as reservoir of O. tsutsugamushi. Rats, mice, and larger mammals are the usual hosts
Scrub typhus is a mild and self-limiting disease, but if untreated it has a fatality of 7%. The condition manifests with severe headache, fever, myalgia, and rash.
Tetracyclines, doxycycline, or chloramphenicol are highly effective in treatment of scrub typhus.
Ehrlichia
Ehrlichia are small, Gram-negative, obligate, intracellular bacilli that parasitize mononuclear and granulocytic phagocytes but not erythrocytes. The genus Ehrlichia is named after the scientist Paul Ehrlich. The first case of Ehrlichia infection in humans was reported in Japan in 1954. The intracellular location of these pathogens protects them from immune response of the host. Inside the cell, they are able to prevent fusion of phagosome with lysosome of monocytes or granulocytes, hence are not lysed by the host's antibody response.
Ehrlichia species cause three clinical syndromes: (a) sennetsu fever, (b) human monocytic ehrlichiosis, and (c) human granulocytic ehrlichiosis
Sennetsu fever is a tick-borne disease restricted to Japan. Human monocytic ehrlichiosis is distributed mainly in the southeastern, mid-Atlantic, and south-central parts of the United States.
Doxycycline is the drug of choice for treatment of human ehrlichiosis. Chloramphenicol and fluoroquinolones are not that effective.
Coxiella
The genus Coxiella was originally classified with rickettsia because the bacteria showed features of a rickettsial pathogen
The genus Coxiella includes the species C. burnetii, which causes Q fever
Coxiella burnetii
Q Fever
The incubation period is 20 days. The acute stage of Q fever manifests as sudden onset of severe headache, high fever, chills, and myalgia. The bacteria produce a respiratory infection mimicking the atypical pneumonia. They also cause hepatosplenomegaly, which is found in approximately half of the patients. The chronic form of Q fever has a long incubation period varying from months to years. Onset of the disease is usually insidious. Subacute endocarditis on a previously damaged heart valve or a prosthetic heart valve is the most common manifestation of the condition. Hepatitis and meningoencephalitis are the other manifestations of the disease. Uncomplicated acute disease is a self-limiting disease, which lasts for 1-2 years. Complications in chronic diseases may increase mortality rate to as high as 30-60%.
Q fever is a zoonosis distributed worldwide. Farm animals, such as sheep, cattle, and goats as well as cats, dogs, and rabbits are primary reservoirs of infection. Ixodid ticks are responsible for transmitting the disease to rodents and domestic animals and for maintaining infection in these animals
Treatment with tetracyclines, such as doxycycline, is effective for acute Q fever. A combination of a tetracycline and cotrimoxazole or rifampicin for a prolonged period is essential for treatment of subacute endocarditis and other chronic diseases caused by C. burnetii.
Chlamydia and Chlamydophila
The taxonomy of Chlamydia has undergone extensive revision recently on the basis of genomic studies of this microorganism. The species C. trachomatis is included in the genus Chlamydia, whereas C. psittaci and C. pneumoniae are included in the new genus Chlamydophila.
Chlamydia
Chlamydiae are obligate intracellular parasites of humans and animals with marked affinity for the squamous epithelial cells of the gastrointestinal and respiratory tracts.
chlamydiae occur in two morphologically distinct forms: elementary body and reticulate body. Elementary body: The elementary body (EB) is a small, extracellular, infective form. It is a round particle measuring 300–400 nm in size. Reticulate body: The reticulate body (RB) is a large, noninfectious form of Chlamydia. It measures 500–1000 nm in size. It is metabolically active and replicating form of Chlamydia.
Infection is initiated by the attachment of the EB to the microvilli of susceptible epithelial cells followed by penetration into the host cell. Inside the host cells, EB remains within the cytoplasmic phagosomes in which EBs begin to multiply.
Chlamydia trachomatis
C. trachomatis is a strict human pathogen. C. trachomatis are Gram-negative bacteria. However, they can be stained better by Giemsa,
Culture
C. trachomatis grows better in various tissue cultures, using nonreplicating stationary-phase cells. The bacteria can grow in a few cell lines, such as HeLa-229, McCoy, BHK-21, and buffalo green monkey kidney cells. McCoy and HeLa cells are frequently used for the isolation of the bacteria.
Chlamydiae are heat-labile bacteria and are readily killed within minutes by heating at 56oC. They are susceptible to ethanol, ether, phenol, formalin, iodine, potassium permanganate, sodium hypochlorite, silver nitrite, and chlorite.
The ability to multiply intracellularly in the infected cell is the key mechanism of virulence of C. trachomatis. The bacteria prevent fusion of phagolysosome with cellular liposomes, thereby preventing intracellular killing of the bacteria by the host cell.
Pathogenesis
C. trachomatis causes disease mainly by (a) direct destruction of infected host cells during multiplication and (b) inducing inflammatory responses in the host. C. trachomatis enters the host through minute abrasions or injuries in the skin. Infections with trachoma serovars are associated with severe inflammatory reaction consisting of neutrophils, lympho cytes, and plasma cells as seen in case of trachoma.
C. trachomatis causes a variety of diseases. It is an important cause of genital and ocular infections worldwide. C. trachomatis LGV biovar causes lymphogranuloma venereum (LGV) and ocular LGV. C. trachomatis trachoma biovar causes (a) trachoma, (b) adult inclusion conjunctivitis, (c) neonatal conjunctivitis, (d) infant pneumonia, and (e) urogenital infections
Urogenital infection is the most common infection caused by C. trachomatis. Approximately, 80% of infected females and 50% of infected males are asymptomatic. Genital chlamydiasis is the most common sexually transmitted disease worldwide. The clinical manifestations in symptomatic patients include urethritis (nongonococcal urethritis), epididymitis, proctitis, and conjunctivitis in males; in females, it causes a mucopurulent cervicitis, endometritis, and salpingitis.
LGV caused by C. trachomatis is highly prevalent in Asia, Africa, and South America. The disease occurs sporadically in Europe, Australia, and North America. LGV is responsible for 10% of genital ulcer disease in developing countries. Trachoma is worldwide in distribution and nearly 500 million people are infected worldwide. The infection is endemic in the Middle East, Africa, Far East, and India.
Diagnosis
Specimens from urethra, cervix, rectum, oropharynx, and conjunctiva are the frequently collected specimens. In addition, other specimens such as, blood, respiratory secretions, sputum, lung, and other tissues are collected and examined. Pus from bubo is also useful for diagnosis of LGV.
Laboratory diagnosis of chlamydial infection is made by microscopic examination of various clinical specimens for demonstration of chlamydial inclusion bodies. These inclusion bodies can be demonstrated in specimens stained by Giemsa, Castaneda, Machiavello, or Gimenez stains.
Serodiagnosis is based on detection of antibodies against C. trachomatis in serum. Patients with LGV show a very high level of serum antibodies.
Frei's skin test: Frei's test is an intradermal skin test used for the diagnosis of LGV. A heat-inactivated C. trachomatis LGV serovar grown in the yolk sac of embryonated egg is used as antigen and 0.1 mL of antigen is injected intradermally in the forearm and a control antigen prepared from uninfected yolk sac is injected in the other forearm.
Treatment
Azithromycin is the drug of choice for treatment of genital chlamydial infections. This antibiotic has the advantage of being given in a single dose regimen and has high tolerability and few contraindications. Tetracyclines are usually recommended for treatment of patients with LGV for at least 3 weeks.
Doxycycline for 7 days or fluoroquinolone (e.g., ofloxacin) for 7 days is also effective for treatment of genital and ocular infections.
Prevention and Control
Chlamydial diseases can be prevented by immediate treatment at early stage of the disease and by taking measures to prevent re-exposure to the bacteria. Chlamydial genital infections are prevented by using safe sexual practices and by prompt treatment of symptomatic patients and their partners.
Chlamydophila
Chlamydophila pneumoniae
C. pneumoniae is the third common cause of pneumonia following Streptococcus pneumoniae and Haemophilus influenzae. It is an important cause of respiratory disease in older children and adults worldwide. C. pneumoniae causes mostly asymptomatic infections. Pharyngitis, sinusitis, bronchitis, and pneumonia are the common manifestations of symptomatic cases in severe respiratory tract infection.
C. pneumoniae is also a strict human pathogen and does not have any animal reservoir. Infection is transmitted by respiratory secretions from person to person without any intermediate host.
Tetracycline, doxycycline, erythromycin, and azithromycin are given for 10-14 days for treatment of C. pneumoniae infection.
Chlamydophila psittaci
C. psittaci is the causative agent of psittacosis, a disease of parrots and psittacine birds which can be transmitted to humans. Infection in birds may occur as asymptomatic or symptomatic. Symptomatic infection may manifest as respiratory infection, diarrhea, and emaciation. C. psittaci can be transmitted from birds to humans as well as sheep, cows, and goat. Humans acquire the infection mostly from psittacine birds, such as parrots, parakeets, cockatiels, and macaws. Human infections are mostly occupational, and veterinarians, poultry workers, pet-shop workers, pigeon farmers, etc. are at increased risk for this infection
Diagnosis
Laboratory diagnosis of the condition is based mainly on the serological tests. Demonstration of a fourfold rise in antibody titer in the paired acute and convalescent sera by the CFT is suggestive of C. psittaci infection.
Tetracycline, doxycycline, erythromycin, and azithromycin are useful for treatment of C. psittaci infection. Infection is prevented by controlling it in birds.
Other Bacteria
In this section, we will include important bacteria such as Listeria monocytogenes, Erysipelothrix rhusiopathiae, Alcaligenes faecalis, Chromobacterium violaceum, Flavobacterium meningosepticum, Calymmatobacterium granulomatis, Streptobacillus moniliformis, Spirillum minus, Legionella pneumophila, Bartonella species, Capnocytophaga species, and Gardnerella vaginalis
Listeria monocytogenes
L. monocytogenes is a small (1-3 X 0.5 µm) Gram-positive bacillus with a tendency to occur in chains. The bacteria show a slow tumbling type of motility by means of peritrichous flagella at 22-25oC, but are nonmotile at 37oC.
The bacteria is aerobic or microaerophilic. It is non-sporing, noncapsulated and non acid fast.It can grow on ordinary medium, but grows better on blood agar to form smooth round translucent and non-pigmented colonies. On blood agar, they produce a narrow zone of weak beta hemolysis. Due to this hemolysis, the colonies of L. monocytogenes may be confused with those of group B streptococci.
L. monocytogenes ferments sugars like glucose, salicine, and aesculin with production of acid. It is oxidase, urease, indole, and H2S negative.
L. monocytogenes produces a variety of infections in pregnant women, neonates, adults, and elderly people. The bacteria in nonpregnant ladies may cause asymptomatic or mild febrile illness. However, infection in pregnant ladies may cause abortion or stillbirth of the child.
L. monocytogenes is distributed worldwide. It occurs as a saprophyte in soil, water, and sewage. It is also widely prevalent in different mammals or birds, fish, ticks, and crustaceans. The bacteria have been isolated from milk, cheese, and other milk products. The infection is transmitted by ingestion of milk, milk products, and other food preparations contaminated with the bacteria, direct contact with infected animal or animal products, and inhalation of contaminated dust.
Treatment is accomplished through the use of ampicillin, gentamicin, and cotrimoxazole. Cephalosporins are not useful for infections caused by Listeria
Erysipelothrix rhusiopathiae
E. rhusiopathiae is a slender, straight or slightly curved, Gram positive bacillus with a tendency toward formation of long
filaments. It is nonmotile, nonsporing, and noncapsulated. It
is catalase, MR, VP, indole, urease, H2S,
and nitrate negative. It ferments glucose and lactose, producing
acid but no gas. It is aerobic and facultative
anaerobic. The growth is improved in the presence of 5-10% CO2
.
It can grow on nutrient agar and also on blood agar.
After 24-48 hours of incubation, it produces convex and
translucent colonies surrounded by a variable zone of
alpha-hemolysis. On tellurite agar, it produces black colonies.
E. rhusiopathiae in humans causes septicemia, endocarditis, and erysipeloid. The latter is a localized infection of the skin that resembles streptococcal erysipelas.
Diagnosis of the condition is made by the isolation of E. rhusiopathiae from pus and other clinical specimens by culture. The bacillus is sensitive to penicillin, erythromycin, ampicillin, methicillin, ciprofloxacin, and clindamycin.
Flavobacterium meningosepticum
It is a Gram-negative, nonsporing, and nonmotile bacterium. It is catalase and oxidase positive and weakly fermentative. It can grow on ordinary medium, such as nutrient agar producing smooth, circular, and glistening colonies after 24 hours of incubation at 37oC.
It can cause opportunistic infections and also neonatal meningitis in premature infants and pneumonia in immunocompromised hosts. Novobiocin, rifampicin, clindamycin, and cefoxitin are effective for treatment of F. meningosepticum infections.
Calymmatobacterium
C. granulomatis causes granuloma inguinale, which has an incubation period of few weeks to months. The condition manifests as the presence of subcutaneous nodules on genital organs or in inguinal area. Subsequently, these nodules suppurate and break down, leading to formation of painless granulomatous lesions. The condition is a sexually transmitted disease, transmitted through sexual contact. These organisms are found in the cytoplasm of histiocytes, polymorphonuclear leukocytes or remain free outside the cell. These are called Donovan bodies. About 1-25 bacteria can be found within a mononuclear phagocyte
Tetracyclines, erythromycin, and trimethoprim-sulfamethoxazole are effective for treatment of the condition.
Streptobacillus moniliformis
S. moniliformis is a pleomorphic Gram-negative bacillus that stains poorly with Gram staining. The bacteria may appear as a string of beads containing granules.
The bacterium is a slow grower. It grows on enriched media supplemented with 15% blood, 20% horse or calf serum, or 5% ascitic fluid. It produces discrete, granular or smooth, gray colonies after 3 days of incubation
Penicillin is the antibiotic of choice for treatment of cases of rat-bite fever. Cephalosporins, erythromycin, clindamycin, and tetracycline are also used to treat the condition.
Legionella pneumophila
L. pneumophila is the causative agent of Legionnaire's disease, as well as of Pontiac fever.
L. pneumophila is a small, slender, pleomorphic, Gram-negative bacillus. It is motile by means of one or more polar or subpolar flagella. It is nonsporing and non-acid fast.
Pathogenesis and Immunity
L. pneumophila is an obligate or facultative intracellular pathogen. The capability of the bacteria to multiply in macrophages and their ability to prevent phagolysosome fusion are the main determinants of virulence of the bacteria. The bacteria infect human monocytes and alveolar macrophages. The bacteria multiply in macrophages and monocytes. Once inside the cell, the bacteria are not killed because they prevent fusion of phagolysosome. Subsequently, the bacteria multiply in large numbers in the intracellular vacuoles and produce many enzymes, such as phosphatase, lipase, nuclease, and proteolytic enzymes. Subsequently they lyse and kill the infected host cell.
Incubation period varies from 2 to 10 days. Pneumonia is the primary manifestation of Legionnaire's disease with multilobular consolidation, inflammation, and abscesses in the lung. Fever, chills, dry or nonproductive cough, and pleuritic or nonpleuritic chest pain are the common symptoms of the disease. Hemoptysis is rare. The condition becomes more severe and is associated with much morbidity and high mortality if not treated immediately. Progressive respiratory failure is the most common cause of death in patients with Legionnaire's disease. The mortality may be as high as 80% in untreated patients.
Legionnaire's disease is prevalent worldwide. This is responsible for 2-15% of all community-acquired pneumonia that requires hospitalization.
Diagnosis
Sputum, lung fluid, pleural fluid, transtracheal aspirations, and bronchoalveolar lavage fluid are the respiratory specimens frequently used for the diagnosis of the condition. Blood is also used for culture.
Treatment
Erythromycin or tetracycline is useful for treatment of community-acquired infections. Fluoroquinolones, such as doxycycline, telithromycin, and azithromycin, are recommended for treatment of severe cases. Beta-lactam antibiotics and aminoglycosides are not useful.
Bartonella
Members of the genus Bartonella are very small Gram-negative bacilli transmitted by arthropods.
Bartonella bacilliformis
B. bacilliformis is the causative agent of Oroya fever, an acute febrile illness consisting of severe anemia.
B. bacilliformis are short Gram-negative coccobacilli measuring 0.3-0.5 X 1.0-1.7 µm. The bacteria occur singly, in pairs, in chains, or in clumps. They are motile by the presence of as many as 10 flagella at one pole of the bacteria. They are aerobic and require an optimum pH of 7.8 and optimum temperature of 25-28oC for their growth.
Penicillin, streptomycin, tetracycline, and chloramphenicol are effective for the treatment of B. bacilliformis infection
Gardnerella vaginalis
The bacterium is present as a commensal in the male urethra and vagina. G. vaginalis are small, pleomorphic, Gram-negative rods, which are sometimes Gram variable. They are nonsporing, nonmotile, and noncapsulated. G. vaginalis causes nonspecific vaginitis and cervicitis, frequently in association with anaerobic vaginosis. The condition is characterized by foul-smelling vaginal discharge with a fishy odor and acidic pH.
G. vaginalis is sensitive to penicillin, ampicillin, and trimethoprim. It is resistant to gentamicin, nalidixic acid, and colistin. Metronidazole is the drug of choice.